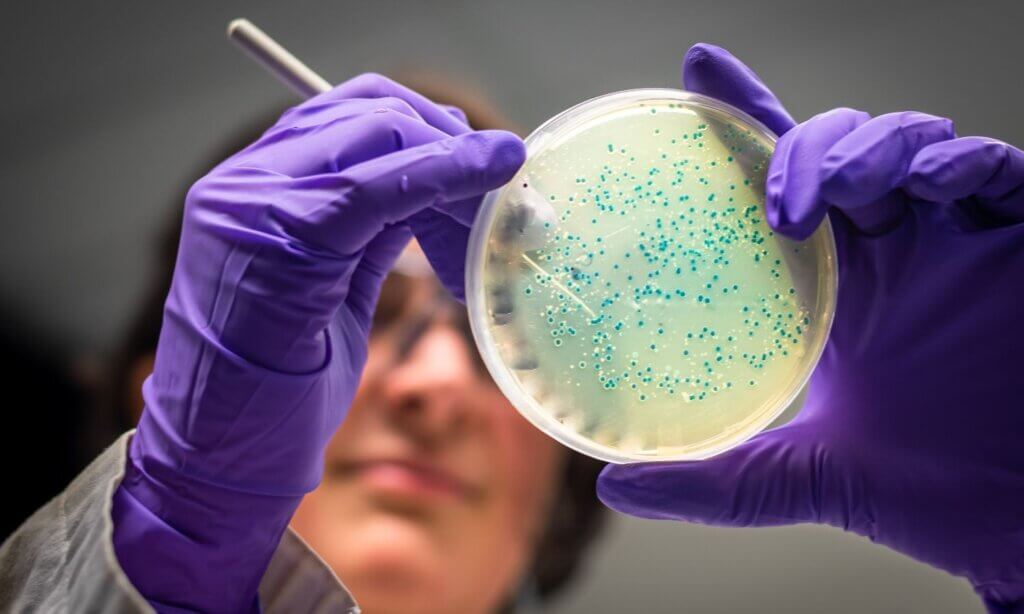
Madeline Bartsch, MSc eröffnete ihren Vortrag mit einem Fallbeispiel: Eine Klientin bringt einen 12-seitigen kommerziellen Mikrobiombefund mit – die entscheidende Frage: Was bedeutet das für die Beratungspraxis?

Ein kompakter Überblick über zentrale Trends, praxisnahe Impulse und interdisziplinäre Entwicklungen aus vier aktuellen Fachveranstaltungen in Österreich.
Du wolltest eigentlich gerne bei den Fachtagungen der letzten Wochen dabei sein, aber die Zeit war zu knapp und der Terminkalender zu voll? Kein Problem – hashtagPRAXIS ist zur Stelle 😉💜 Wir waren für euch im März und April mit dabei bei vier Fachtagungen der Bereiche Osteopathie, Diätologie, Ergotherapie und Psychologie, haben uns zahlreiche Keynotes und Symposien angehört und die Inhalte für euch zusammengefasst.
Inhalt
6. Fachtagung für Osteopathie (OEGO)
Die 6. Fachtagung der Österreichischen Gesellschaft für Osteopathie (OEGO) sendete ein klares Signal in Richtung Gesundheitspolitik: Die Forderung nach gesetzlicher Anerkennung der Osteopathie als eigenständiger Gesundheitsberuf ist lauter denn je. Mit prominenten Gästen aus dem Gesundheitswesen, darunter der Obmann der Österreichischen Gesundheitskasse Andreas Huss, und einem hochkarätigen internationalen Fachprogramm zeigte die Veranstaltung zugleich, wie breit und wissenschaftlich fundiert das Spektrum der Osteopathie heute ist.
OEGO-Präsidentin Margit Halbfurter-Mandler verwies auf die europäische Realität: In 13 Ländern ist Osteopathie bereits gesetzlich verankert, allein in den vergangenen sechs Jahren haben sieben Staaten entsprechende Regelungen geschaffen – darunter Italien, das den Prozess 2025 vollständig abgeschlossen hat, und Deutschland, das die berufsgesetzliche Regelung im Koalitionsvertrag festgeschrieben hat. Österreich, so die unmissverständliche Botschaft der Tagung, darf hier nicht weiter zurückbleiben.
Training des sozialen Gehirns – Empathie, Mitgefühl und mentale Gesundheit

Der Vortrag von Prof. Dr. Tania Singer widmete sich der Frage, wie soziale und emotionale Fähigkeiten – insbesondere Empathie, Mitgefühl und Perspektivübernahme – neurobiologisch verstanden und gezielt trainiert werden können. Ausgangspunkt war die Beobachtung zunehmender gesellschaftlicher Herausforderungen wie Einsamkeit, Stress und psychische Belastungen, die sich insbesondere seit der COVID-19-Pandemie deutlich verschärft haben. (Weiterlesen …)
Grundlagen des sozialen Gehirns
Die Referentin zeigte, dass das sogenannte „soziale Gehirn“ aus unterschiedlichen, klar unterscheidbaren neuronalen Netzwerken besteht. Zentral ist die Differenzierung zwischen Empathie (emotionale Resonanz), Mitgefühl (fürsorgliche, wohlwollende Haltung) und kognitiver Perspektivübernahme (reflektierendes Verstehen anderer Sichtweisen). Diese Unterscheidung ist nicht nur begrifflich, sondern auch biologisch relevant: Während Empathie mit Aktivität in schmerzverarbeitenden Netzwerken einhergeht, aktiviert Mitgefühl Belohnungs- und Fürsorgesysteme. Perspektivübernahme wiederum beruht auf kognitiven Kontroll- und Reflexionsprozessen.
Empathie vs. Mitgefühl – eine zentrale Differenz
Ein zentrales Ergebnis der Forschung ist die klare Trennung zwischen Empathie und Mitgefühl. Empathie bedeutet, das Leid anderer mitzuerleben – was bei hoher Intensität zu „empathischem Stress“ und langfristig zu Burnout führen kann. Mitgefühl hingegen beschreibt eine Haltung von Wärme, Fürsorge und Stabilität gegenüber dem Leid anderer, ohne selbst darin aufzugehen. Diese Unterscheidung ist insbesondere für Gesundheitsberufe von großer Bedeutung, da sie einen Schlüssel zur Prävention von Überlastung darstellt.
Trainierbarkeit sozialer Fähigkeiten
Im Rahmen groß angelegter Studien (u. a. des ReSource-Projekts) konnte gezeigt werden, dass sich soziale und emotionale Kompetenzen systematisch trainieren lassen. In mehrmonatigen Programmen wurden drei Trainingsbereiche unterschieden:
- Aufmerksamkeit (Achtsamkeit)
- Sozio-emotionale Fähigkeiten (Empathie und Mitgefühl)
- Kognitive Perspektivübernahme (Metakognition)
Die Ergebnisse zeigen, dass bereits tägliches Training von etwa 30 Minuten zu messbaren Veränderungen in Gehirnstruktur und Verhalten führt. Je nach Trainingsinhalt verstärken sich gezielt unterschiedliche neuronale Netzwerke. Gleichzeitig verbessern sich Aufmerksamkeit, emotionale Regulation und soziale Kompetenzen.
Stressreduktion und Resilienz
Ein besonders relevantes Ergebnis betrifft die Stressverarbeitung: Während Achtsamkeitstraining allgemeine Stressreaktionen reduziert, wirkt sich insbesondere das Training sozialer Fähigkeiten deutlich auf sozialen Stress aus. In Studien konnte eine Reduktion von sozialem Stress um bis zu 50 % nachgewiesen werden. Dies unterstreicht die Bedeutung zwischenmenschlicher Kompetenzen für die psychische Gesundheit.
Die Rolle sozialer Interaktion: Dyadisches Training
Ein innovativer Bestandteil der Programme ist das sogenannte dyadische Training – strukturierte Partnerübungen, bei denen zwei Personen regelmäßig miteinander in einen angeleiteten Austausch treten. Dabei geht es weniger um Inhalte als um das bewusste Wahrnehmen eigener Gefühle im Körper sowie um empathisches bzw. mitfühlendes Zuhören ohne Bewertung oder Ratschläge.
Diese Praxis zeigte mehrere Effekte:
- Stärkung von sozialer Verbundenheit
- Reduktion von Einsamkeit
- Verbesserung von emotionaler Selbstwahrnehmung
- Förderung von Resilienz und Vertrauen
Gerade im Kontext zunehmender sozialer Isolation wird diese Form der Interaktion als besonders wirksam hervorgehoben.
Gesellschaftliche Relevanz und Skalierung
Die Forschungsergebnisse wurden in den letzten Jahren zunehmend in skalierbare Programme überführt, etwa in Form digitaler Anwendungen. Studien während der Pandemie zeigten, dass bereits kurze tägliche Übungen (ca. 13 Minuten) positive Effekte auf Angst, Depression und soziale Verbundenheit haben können – insbesondere dann, wenn sie interaktive Elemente enthalten.
Pilotprojekte im Bildungs- und Gesundheitswesen belegen zusätzlich systemische Effekte: Verbesserte mentale Gesundheit bei Fachkräften geht mit positiveren sozialen Dynamiken, etwa im Klassenklima oder in der Patienteninteraktion, einher.
Implikationen für Gesundheitsberufe
Für therapeutische und medizinische Berufe ergibt sich daraus ein klarer Auftrag: Soziale und emotionale Kompetenzen sind nicht nur „Soft Skills“, sondern trainierbare, neurobiologisch verankerte Fähigkeiten mit direkter Relevanz für Gesundheit, Beziehungsqualität und berufliche Resilienz. Besonders wichtig ist dabei die Fähigkeit, zwischen Empathie und Mitgefühl zu unterscheiden und bewusst zwischen beiden Zuständen wechseln zu können.
Der Vortrag verdeutlichte, dass mentale Gesundheit und soziale Fähigkeiten eng miteinander verknüpft sind und sich gezielt entwickeln lassen. Die Kombination aus neurowissenschaftlicher Forschung und praktischen Trainingsansätzen eröffnet neue Wege für Prävention, Therapie und gesellschaftlichen Zusammenhalt. Insbesondere in Zeiten wachsender psychischer Belastungen bieten diese Ansätze ein evidenzbasiertes Fundament für nachhaltige Gesundheitsförderung auf individueller wie struktureller Ebene.
Narben und ihre verborgenen Auswirkungen – fasziale Verklebungen verstehen und behandeln

Der Vortrag der Narben-Spezialistin Michaela Liedler MSc D. O. rückte ein oft unterschätztes Thema in den Fokus: die weitreichenden Folgen von Narben und inneren Verklebungen auf den gesamten Körper. Ausgehend von ihrer eigenen Erfahrung nach einem Kaiserschnitt zeigte die Referentin eindrücklich, dass Beschwerden häufig nicht an der sichtbaren Narbe selbst entstehen, sondern in tiefer liegenden Gewebeschichten, die sich der direkten Betrachtung entziehen. (Weiterlesen …)
Unsichtbare Ursachen chronischer Beschwerden
Liedler verdeutlichte, dass postoperative Verklebungen, aber auch Entzündungen oder chronischer Stress, tiefgreifende Veränderungen im Körper hervorrufen können. Obwohl Narben äußerlich oft unauffällig erscheinen, können sie im Inneren ein komplexes Netzwerk an Verklebungen bilden. Diese betreffen das fasziale System und führen zu Bewegungseinschränkungen sowie vielfältigen Symptomen – von lokalen Schmerzen über funktionelle Störungen bis hin zu weit entfernten Beschwerden wie Kopf-, Rücken- oder Verdauungsproblemen. Charakteristisch ist dabei, dass die eigentliche Ursache häufig nicht dort liegt, wo der Schmerz wahrgenommen wird.
Das fasziale System als Schlüsselstruktur
Im Zentrum des Vortrags stand das Verständnis des Fasziensystems als ganzheitliches Netzwerk, das den gesamten Körper durchzieht und wesentlich für Bewegung, Kraftübertragung und Körperwahrnehmung (Propriozeption) ist. In einem gesunden Zustand ermöglichen gleitfähige Gewebeschichten eine präzise Informationsweiterleitung zwischen Körper und Gehirn. Verklebungen hingegen stören diese Prozesse: Sie verändern die mechanischen Eigenschaften des Gewebes, schränken die Gleitfähigkeit ein und führen zu fehlerhaften Rückmeldungen an das Nervensystem.
Diese „verzerrten“ Informationen können dazu führen, dass Bewegungen nicht mehr korrekt angesteuert werden, Muskeln ineffizient arbeiten oder kompensatorische Spannungsmuster entstehen. Langfristig begünstigt dies chronische Schmerzen und Überlastungen, da der Körper versucht, die gestörten Funktionen auszugleichen.
Verklebungen als systemisches Problem
Besonders eindrücklich beschrieb Liedler, wie sich Verklebungen kettenartig durch den Körper ziehen können. Ähnlich einem Knoten in einem Gewebe erzeugen sie Zugspannungen, die sich auf andere Körperregionen übertragen. Dadurch entsteht ein permanenter Anpassungsdruck im gesamten System. Klassische Maßnahmen wie Dehnen greifen hier zu kurz, da sie die strukturellen Veränderungen der verklebten Gewebeschichten nicht auflösen, sondern im ungünstigen Fall sogar verstärken können.
Auswirkungen auf Wahrnehmung und Selbstregulation
Ein zentraler Aspekt des Vortrags war die Bedeutung der Körperwahrnehmung für die Selbstregulation. Das Gehirn ist auf präzise Rückmeldungen aus dem Körper angewiesen, um Bewegungen zu steuern und Sicherheit zu bewerten. Werden diese Signale durch Verklebungen verfälscht, entsteht eine Art „Fehlinformation“, die zu Unsicherheit, Fehlsteuerung und verstärkter Spannung führen kann. Dies erklärt, warum Betroffene trotz gezielter Übungen oft keinen nachhaltigen Trainingseffekt erzielen.
Therapeutischer Ansatz: Wiederherstellung von Beweglichkeit und Information
Als Lösungsansatz stellte die Referentin ein Konzept vor, das gezielt an den verklebten Gewebeschichten ansetzt. Im Unterschied zu druckorientierten Techniken liegt der Fokus auf sogenannten Scherbewegungen, die darauf abzielen, die verklebten Strukturen in die Tiefe hinein wieder beweglich zu machen. Entscheidend ist dabei die Kombination aus achtsamer Berührung, gezielter Bewegung und der Einbindung des Nervensystems.
Ziel der Behandlung ist nicht nur die mechanische Lösung von Verklebungen, sondern auch die Wiederherstellung einer stimmigen Kommunikation zwischen Körper und Gehirn. Durch verbesserte Gleitfähigkeit und differenziertere Wahrnehmung können sich Bewegungsmuster normalisieren, Spannungen reduzieren und Schmerzen nachhaltig beeinflusst werden.
Veränderbarkeit auch langfristiger Narben
Ein ermutigender Befund des Vortrags: Auch lange bestehende Narben und Verklebungen sind veränderbar. Da sich Gewebestrukturen wie Kollagen kontinuierlich erneuern, besteht grundsätzlich die Möglichkeit, funktionelle Verbesserungen zu erreichen – unabhängig davon, wie lange eine Operation zurückliegt.
Der Vortrag machte deutlich, dass Narben weit mehr sind als ein lokales Hautphänomen. Sie können das gesamte Bewegungssystem sowie die Körperwahrnehmung nachhaltig beeinflussen. Gleichzeitig eröffnen gezielte, faszienorientierte Therapieansätze neue Möglichkeiten, diese oft verborgenen Ursachen von Beschwerden zu behandeln. Für therapeutische Berufe ergibt sich daraus die wichtige Erkenntnis, Narben stets im Kontext des gesamten Körpersystems zu betrachten und in Diagnostik und Behandlung entsprechend zu berücksichtigen.
Migräne im Fokus – die Wichtigkeit von interdisziplinärer und individueller Therapie

Der dänische Kopfschmerzforscher und klinische Wissenschaftler Dr. Thien Phu Do MD, PhD gab in seinem Vortrag einen umfassenden Überblick über den aktuellen Stand der Migräneforschung und -behandlung. Ausgehend von seiner Arbeit am Dänischen Kopfschmerzzentrum, wo schwer therapierbare Fälle interdisziplinär betreut werden, betonte er zunächst die enorme gesellschaftliche Relevanz der Erkrankung. (Weiterlesen …)
Hohe Verbreitung und unterschätzte Erkrankung
Migräne betrifft weltweit rund eine Milliarde Menschen und ist eine der häufigsten Ursachen für Einschränkungen im erwerbsfähigen Alter. Auch in Österreich ist die Prävalenz hoch – rund 19 % der Erwachsenen berichten über entsprechende Beschwerden innerhalb eines Jahres, wobei Migräne häufig bereits im Jugendalter beginnt. Ein zentrales Problem sei die nach wie vor unzureichende Versorgung: Viele Betroffene suchen keine medizinische Hilfe, Migräne werde oft unterschätzt, unterdiagnostiziert und unzureichend behandelt.
Vielfältige Erscheinungsformen der Migräne
Dabei handelt es sich keineswegs um ein einheitliches Krankheitsbild, sondern um eine komplexe neurologische Störung mit unterschiedlichen Ausprägungen – etwa Migräne mit oder ohne Aura sowie chronische Migräne. Typische Symptome sind ein meist halbseitiger, pulsierender Kopfschmerz, der durch Bewegung verstärkt wird und mit Begleiterscheinungen wie Licht- und Geräuschempfindlichkeit, Übelkeit oder Erbrechen einhergeht. Allerdings entsprechen viele Patientinnen und Patienten nicht dem klassischen Lehrbuchbild, was die Diagnose erschwert.
Mehr als nur Kopfschmerz: Phasen der Erkrankung
Neben der eigentlichen Schmerzphase spielen auch Vor- und Nachphasen eine wichtige Rolle, in denen Betroffene etwa unter Müdigkeit, Konzentrationsproblemen oder Heißhunger leiden. Diese Aspekte würden in der Praxis häufig unterschätzt, obwohl sie die Lebensqualität stark beeinträchtigen können.
Neurologische Grundlagen und Auslöser
Pathophysiologisch steht vor allem das sogenannte trigeminovaskuläre System im Fokus, dessen Überempfindlichkeit bei Migräne-Patientinnen und -Patienten zu einer Aktivierung schmerzverarbeitender Strukturen führt. Bestimmte körpereigene Botenstoffe können bei anfälligen Personen Migräneattacken auslösen – ein Mechanismus, der heute gezielt therapeutisch genutzt wird.
Diagnostik zwischen Schema und Realität
In der Diagnostik sei es entscheidend, primäre Kopfschmerzerkrankungen wie Migräne von sekundären Ursachen – etwa Tumoren oder Schlaganfällen – zu unterscheiden. Hierfür existieren sogenannte „Red Flags“, die auf ernsthafte Grunderkrankungen hinweisen können. Gleichzeitig plädierte Do für mehr Flexibilität in der Anwendung diagnostischer Kriterien, da viele Betroffene nicht eindeutig in bestehende Schemata passen.
Akuttherapie und Prävention
Therapeutisch unterscheidet man zwischen akuter Behandlung und Prophylaxe. In der Akuttherapie kommen zunächst klassische Schmerzmittel wie NSAR zum Einsatz, gefolgt von spezifischen Migräne-Medikamenten (Triptanen). Entscheidend sei der richtige Einnahmezeitpunkt: Medikamente sollten möglichst früh in der Attacke eingenommen werden, da sie bei fortgeschrittener Schmerzverarbeitung im Gehirn weniger wirksam sind. Für Patientinnen und Patienten mit häufigen oder schweren Attacken stehen vorbeugende Therapien zur Verfügung, darunter Blutdruckmedikamente, Antikonvulsiva, Botulinumtoxin sowie moderne Antikörpertherapien gegen CGRP, die als besonders wirksam gelten, jedoch kostenintensiv sind.
Nicht-medikamentöse Ansätze im Fokus
Einen breiten Raum nahm im Vortrag die nicht-medikamentöse Therapie ein, die für viele Patientinnen und Patienten eine wichtige Ergänzung darstellt. Dazu zählen unter anderem kognitive Verhaltenstherapie, Ernährungsanpassungen, Bewegung, Schlafhygiene und alternative Verfahren wie Akupunktur. Die Studienlage sei hier oft uneinheitlich: Während viele Ansätze die Lebensqualität verbessern können, zeigen sie nicht immer eine klare Reduktion der Kopfschmerztage.
Mythen und Missverständnisse bei Triggern
Besonders kritisch sieht Do pauschale Empfehlungen zu vermeintlichen „Triggern“ wie bestimmten Lebensmitteln – häufig handle es sich um Fehlinterpretationen, etwa wenn Heißhunger Teil der Migräne-Vorphase ist und nicht deren Ursache. Migräne sei vielmehr eine sogenannte „Schwellen-Erkrankung“, bei der mehrere Faktoren zusammenwirken.
Sonderfall posttraumatische Kopfschmerzen
Abschließend ging Do auf posttraumatische Kopfschmerzen ein, die nach Schädel-Hirn-Traumata auftreten und häufig migräneähnlich sind, jedoch schlechter auf klassische Migränetherapien ansprechen. Hier bestehe noch erheblicher Forschungsbedarf.
Komplexe Erkrankung erfordert individuelle Therapie
Insgesamt machte der Vortrag deutlich, dass Migräne eine komplexe, vielschichtige Erkrankung ist, die eine individualisierte und oft interdisziplinäre Behandlung erfordert. Neben pharmakologischen Ansätzen gewinnen dabei ganzheitliche Strategien zunehmend an Bedeutung – nicht zuletzt, weil sie die Lebensqualität der Betroffenen nachhaltig verbessern können.
Mikrobiom als Schlüssel zur Schmerzregulation – die Verbindung von Darm, Hirn und Immunsystem

Im Rahmen ihres Vortrags beleuchtete die Ernährungs- und Sportwissenschaftlerin Simone Kummerhofer BA, BSc, MSc vom Institut AllergoSan die zentrale Rolle des Mikrobioms für die Schmerzwahrnehmung. Im Fokus stand dabei die enge Verbindung zwischen Darm, Gehirn und Immunsystem – insbesondere über den Vagusnerv – sowie die Frage, inwieweit sich diese Zusammenhänge therapeutisch nutzen lassen, etwa durch Ernährung oder probiotische Ansätze. (Weiterlesen …)
Das Mikrobiom als aktives Stoffwechselorgan
Kummerhofer machte deutlich, dass der menschliche Körper zu einem erheblichen Teil aus Mikroorganismen besteht – allein das Darmmikrobiom wiegt etwa zwei Kilogramm. Entscheidend für die Gesundheit ist dabei weniger die bloße Anwesenheit von Bakterien, sondern deren Aktivität: Sie verstoffwechseln Nährstoffe und produzieren sogenannte Metaboliten, die weitreichende Effekte auf den Organismus haben.
Eine hohe mikrobielle Diversität gilt als zentraler Gesundheitsfaktor. Umgekehrt führt eine reduzierte Vielfalt (Dysbiose) zu Veränderungen im Immunsystem und kann zahlreiche Erkrankungen begünstigen.
Darm-Hirn-Schmerz-Achse: Wie Mikroben Schmerzen beeinflussen
Ein zentrales Konzept des Vortrags war die sogenannte Darm-Hirn-Schmerz-Achse („gut-brain-pain axis“). Über verschiedene Kommunikationswege – immunologisch, neuronal und metabolisch – beeinflusst das Mikrobiom die Verarbeitung von Schmerzreizen im Gehirn.
Besonders relevant sind:
- Immunologische Prozesse: Bakterien und ihre Stoffwechselprodukte modulieren Entzündungsreaktionen, die wiederum die Schmerzempfindlichkeit beeinflussen.
- Neuronale Signalwege: Über den Vagusnerv steht der Darm in direkter Verbindung mit dem Gehirn.
- Metaboliten: Kurzkettige Fettsäuren wie Butyrat wirken entzündungshemmend und beeinflussen Schmerzrezeptoren direkt.
Damit wird deutlich: Veränderungen im Mikrobiom können sowohl die Entstehung als auch die Intensität von Schmerzen – etwa bei funktionellen Beschwerden oder Migräne – maßgeblich mitbestimmen.
Dysbiose, „Leaky Gut“ und chronische Beschwerden
Eine gestörte Darmflora kann laut Kummerhofer eine Kaskade an gesundheitlichen Problemen auslösen. Zunächst kommt es zu einer Dysbiose, gefolgt von Veränderungen der Darmschleimhaut und schließlich zu einer erhöhten Durchlässigkeit der Darmbarriere („Leaky Gut“).
Die Folgen:
- vermehrter Übertritt von bakteriellen Bestandteilen ins Blut
- Aktivierung des Immunsystems
- chronische Entzündungsprozesse
- gesteigerte Schmerzempfindlichkeit
Solche Mechanismen stehen in Zusammenhang mit Erkrankungen wie Reizdarmsyndrom, Migräne oder Endometriose.
Einfluss von Lebensstil, Ernährung und Medikamenten
Das Mikrobiom wird maßgeblich durch den Lebensstil geprägt. Besonders wichtig sind:
- Ernährung: Ballaststoffreiche Kost fördert gesundheitsrelevante Bakterien, während stark verarbeitete Lebensmittel die Diversität reduzieren.
- Stress: Hormonelle Veränderungen beeinflussen die bakterielle Zusammensetzung direkt.
- Medikamente: Nicht nur Antibiotika, sondern auch Schmerzmittel oder andere Arzneien verändern das Mikrobiom teils erheblich.
Interessant: Bereits innerhalb weniger Tage kann sich die Zusammensetzung des Mikrobioms durch Ernährungsumstellung deutlich verändern.
Probiotika und Ernährung als therapeutische Ansätze
Ein Schwerpunkt des Vortrags lag auf möglichen Interventionen. Kummerhofer unterschied dabei zwischen:
- Probiotika: lebende Mikroorganismen mit gesundheitlichem Nutzen
- Präbiotika: „Futter“ für nützliche Bakterien (z. B. Ballaststoffe)
- Postbiotika: Stoffwechselprodukte von Bakterien
Studien zeigen, dass bestimmte probiotische Stämme:
- die Schmerzverarbeitung im Gehirn beeinflussen können
- Angst und Stress reduzieren
- die Schlafqualität verbessern
- insbesondere bei gastrointestinalen Beschwerden wirksam sind
Allerdings betonte Kummerhofer die große Bedeutung der Qualität und Spezifität der eingesetzten Bakterienstämme sowie die Notwendigkeit einer individuellen Betrachtung.
Gender-Aspekte und individuelle Unterschiede
Ein weiterer wichtiger Punkt war der sogenannte Gender Bias in der Forschung. Frauen und Männer unterscheiden sich sowohl im Mikrobiom als auch in der Schmerzverarbeitung und Medikamentenwirkung deutlich. Hormonelle Einflüsse spielen hierbei eine zentrale Rolle, weshalb geschlechtsspezifische Forschung künftig stärker berücksichtigt werden müsse.
Zudem ist das Mikrobiom hochindividuell – vergleichbar mit einem Fingerabdruck. Standardisierte Therapieansätze greifen daher oft zu kurz.
Große Chancen, aber noch Forschungsbedarf
Abschließend unterstrich Kummerhofer das enorme Potenzial mikrobiombasierter Therapieansätze – insbesondere in der Kombination aus gezielter Ernährung und probiotischer Intervention. Gleichzeitig bestehe noch erheblicher Forschungsbedarf, etwa hinsichtlich individueller Unterschiede, optimaler Therapiedauer und spezifischer Wirkmechanismen.
Das Mikrobiom erweist sich damit als zentraler Baustein in einem ganzheitlichen Verständnis von Schmerz – und als vielversprechender Ansatzpunkt für zukünftige Behandlungsstrategien.
Moderne Leistungsmedizin im Profifußball – ganzheitliche Ansätze zwischen Wissenschaft, Praxis und Individualisierung

Der Vortrag von Prof. Dr. Dr. Winfried Banzer bietet einen umfassenden Einblick in die komplexe Welt der Leistungsmedizin im Profifußball. Ausgehend von seinem persönlichen Werdegang, der klassische Medizin, Osteopathie und wissenschaftliche Forschung vereint, zeigt er eindrücklich, wie sich moderne Trainings- und Betreuungskonzepte im Spitzensport entwickelt haben. Am Beispiel seiner Arbeit bei Eintracht Frankfurt wird deutlich, wie wichtig die enge Verzahnung von Wissenschaft und Praxis sowie die Unterstützung durch Trainerstab und Vereinsführung für eine erfolgreiche Umsetzung innovativer Ansätze ist. (Weiterlesen …)
Dynamik des modernen Fußballs und steigende Anforderungen
Ein zentrales Thema des Vortrags ist die enorme Entwicklung des Profifußballs in den letzten Jahren. Die Intensität und Geschwindigkeit des Spiels haben deutlich zugenommen, wodurch hochintensive Laufleistungen und schnelle Richtungswechsel zum Standard geworden sind. Diese Entwicklung führt zu einer erheblichen Steigerung der körperlichen Belastung und damit auch zu einem erhöhten Verletzungsrisiko. Prävention wird dadurch zu einem entscheidenden Erfolgsfaktor im modernen Leistungssport.
Verletzungen als sportlicher und ökonomischer Faktor
Verletzungen betreffen nicht nur die sportliche Leistungsfähigkeit, sondern haben auch erhebliche wirtschaftliche Konsequenzen. Banzer verdeutlicht, dass Ausfallzeiten hohe Kosten verursachen und daher eine systematische Analyse von Verletzungsmechanismen unerlässlich ist. Dabei wird zwischen Kontakt- und Nicht-Kontakt-Verletzungen differenziert, um gezielte Präventionsstrategien zu entwickeln.
Belastungssteuerung und strukturelle Herausforderungen
Die hohe Spielbelastung durch eng getaktete Wettbewerbe stellt eine große Herausforderung dar. Trainings- und Regenerationszeiten müssen präzise abgestimmt werden, während gleichzeitig externe Faktoren – etwa zusätzliche Trainings im Nachwuchsbereich – berücksichtigt werden müssen. Besonders kritisch sieht Banzer die frühe Selektion im Jugendfußball, bei der häufig körperlich früh entwickelte Spieler bevorzugt werden, während Spätentwickler benachteiligt sind.
Interdisziplinäre Zusammenarbeit als Schlüssel
Ein wesentlicher Erfolgsfaktor liegt in der engen Zusammenarbeit verschiedener Fachbereiche. Trainer, Medizin, Athletik, Ernährung, Psychologie und Analyse müssen gemeinsam agieren und eine einheitliche „Sprache“ entwickeln. Ebenso entscheidend ist die Akzeptanz der Spieler, da präventive und therapeutische Maßnahmen nur wirksam sind, wenn sie verstanden und aktiv mitgetragen werden.
Genetik und Epigenetik als neue Perspektiven
Ein bedeutender Schwerpunkt liegt auf der Rolle genetischer Voraussetzungen. Während die genetische Grundausstattung nicht veränderbar ist, eröffnet die Epigenetik neue Möglichkeiten: Training, Lebensstil und soziale Faktoren beeinflussen, wie Gene aktiviert werden. Studien zeigen, dass gezielte Belastungssteuerung sogar biologische Marker verändern kann – etwa in Form einer „Verjüngung“ auf zellulärer Ebene während einer Saison.
Ziel zukünftiger Entwicklungen ist es, durch schnell verfügbare Diagnostik (z. B. Entzündungsmarker) die Belastungssteuerung noch präziser und individueller zu gestalten.
Individualisierung von Training und Therapie
Ein zentrales Leitmotiv des Vortrags ist die Individualisierung. Pauschale Trainingskonzepte greifen zu kurz, da jeder Athlet unterschiedlich auf Belastungen reagiert. Moderne Ansätze nutzen genetische Analysen, funktionelle Diagnostik und manuelle Therapieformen, um maßgeschneiderte Programme zu entwickeln. Dabei spielt auch die osteopathische Betrachtungsweise eine wichtige Rolle, insbesondere im Hinblick auf Beweglichkeit und funktionelle Zusammenhänge.
Strukturierter Alltag im Profisport
Der Alltag im Profifußball ist hochgradig organisiert und datenbasiert. Er umfasst:
- strukturierte Ernährung und gemeinsame Mahlzeiten
- medizinische Untersuchungen vor dem Training
- GPS-Tracking und Leistungsanalysen
- individuell abgestimmte Trainings- und Regenerationsmaßnahmen
Gleichzeitig wird großer Wert auf soziale Interaktion und Teamkultur gelegt, da diese Faktoren maßgeblich zur Leistungsfähigkeit beitragen.
Kognitive Leistungsfähigkeit und Spielintelligenz
Neben der physischen Komponente gewinnt die kognitive Leistungsfähigkeit zunehmend an Bedeutung. Fähigkeiten wie Antizipation, Wahrnehmung („Scanning“) und schnelle Entscheidungsfindung sind entscheidend für den Erfolg auf dem Spielfeld. Diese Prozesse laufen häufig unbewusst ab und können gezielt trainiert werden.
Verletzungsprävention durch moderne Diagnostik
Zur Prävention werden umfangreiche Screening-Verfahren eingesetzt, darunter Bewegungsanalysen, EMG-Messungen sowie Sprung- und Landetests. Ziel ist es, potenzielle Risikofaktoren frühzeitig zu erkennen und individuell zu adressieren. Auch spezielle Protokolle, etwa zur Diagnostik und Behandlung von Kopfverletzungen, spielen eine wichtige Rolle.
Regeneration als integraler Bestandteil der Leistung
Regeneration wird als gleichwertig zum Training betrachtet. Zum Einsatz kommen verschiedene Methoden wie Kompression, Kälte- und Wärmeanwendungen oder Sauerstofftherapie. Neue Technologien werden kritisch geprüft, um ihre tatsächliche Wirksamkeit sicherzustellen.
Ernährung, Schlaf und Lebensstil als Leistungsfaktoren
Ein weiterer zentraler Aspekt ist die ganzheitliche Betrachtung des Athleten. Ernährung umfasst nicht nur die Versorgung im Verein, sondern auch das private Umfeld. Besonders hervorgehoben wird die Bedeutung des Schlafs, der als einer der wichtigsten und zugleich oft unterschätzten Faktoren für Leistung und Regeneration gilt.
Psychischer Druck und soziale Einflüsse
Der mentale Druck im Profisport ist enorm. Spieler werden zwar früh daran gewöhnt, dennoch bleibt der Umgang damit eine große Herausforderung. Besonders der indirekte Druck durch Familie und Umfeld kann belastend sein. Eine stabile Teamkultur sowie gezielte Betreuung sind daher essenziell.
Nachwuchsarbeit und frühe Prävention
Präventive Maßnahmen beginnen bereits im Kindesalter. Ziel ist es, frühzeitig gesunde Bewegungsmuster zu etablieren und Verletzungen vorzubeugen. Gleichzeitig wird auf die Problematik überhöhter Erwartungen im Nachwuchsbereich hingewiesen.
Spezifische Aspekte im Frauenfußball
Im Frauenfußball gewinnt die Berücksichtigung zyklusabhängiger Faktoren zunehmend an Bedeutung. Obwohl wissenschaftliche Erkenntnisse vorliegen, ist die praktische Umsetzung im Trainingsalltag komplex und erfordert individuelle Lösungen.
Datenbasierte Diagnostik und Zukunftsperspektiven
Die moderne Leistungsmedizin ist stark datengetrieben. Blutanalysen, genetische Tests und Monitoring-Systeme liefern umfangreiche Informationen zur individuellen Belastung. Zukünftig könnten schnellere Diagnosesysteme eine noch präzisere Steuerung ermöglichen.
Gleichzeitig bestehen Grenzen: Viele Daten bleiben aus Wettbewerbsgründen innerhalb der Vereine und sind nur eingeschränkt für die Forschung zugänglich.
Der Vortrag macht deutlich, dass moderner Profifußball weit über Training und Taktik hinausgeht. Leistung entsteht aus einem komplexen Zusammenspiel von Genetik, Training, Regeneration, Psyche und sozialem Umfeld. Der Trend geht klar in Richtung Individualisierung, interdisziplinärer Zusammenarbeit und datenbasierter Steuerung.
Damit steht die Leistungsmedizin exemplarisch für die fortschreitende Verwissenschaftlichung des Spitzensports – mit dem Ziel, maximale Leistung bei gleichzeitig langfristigem Erhalt der Gesundheit zu ermöglichen.
43. Ernährungskongress – DIÄTOLOGIE AUSTRIA
Vor ausgebuchtem Saal und im Beisein zahlreicher Ehrengäste aus Gesundheitswesen, MTD-Berufsverbänden und Diätologie-Studiengängen feierte DIÄTOLOGIE AUSTRIA beim 43. Ernährungskongress gleichzeitig sein 65-jähriges Verbandsjubiläum. Gesundheitsstaatssekretärin Ulrike Königsberger-Ludwig würdigte die Pionierarbeit des Verbandes persönlich und bekräftigte das gemeinsame Ziel einer flächendeckenden, einkommensunabhängigen Versorgung.
Verbandspräsidentin Prof. Andrea Hofbauer nutzte die Eröffnung für einen klaren berufspolitischen Appell: Die Kostenübernahme diätologischer Leistungen durch die gesetzlichen Sozialversicherungsträger bleibt das dringlichste nächste Ziel – zumal laut Schätzungen durch die unzureichende Nutzung ernährungstherapeutischer Maßnahmen jährlich bis zu einer Milliarde Euro an vermeidbaren Gesundheitskosten entstehen. Fachlich stand der Kongress diesmal im Zeichen von Mikronährstoffen und bioaktiven Substanzen. Den Auftakt bildete die Verleihung des DIAETAWARD 2026, mit dem wissenschaftliche Arbeiten und innovative Praxisprojekte ausgezeichnet wurden, die die Weiterentwicklung der Diätologie vorantreiben. Wir waren am ersten von zwei Tagen für euch mit dabei!
DIAETAWARD 2026

Der DIAETAWARD 2026 wurde von einer Fachjury bestehend aus Daniel Buchholz, Gabriele Gäbler und Eva Masel vergeben. Die Auszeichnungen umfassten drei Kategorien: NACHWUCHS (Bachelorarbeiten), WISSENSCHAFT & FORSCHUNG (Master- und PhD-Arbeiten) sowie INNOVATIVE DIÄTOLOGISCHE PRAXIS. (Weiterlesen …)
Preis NACHWUCHS
Gewinnerin: Tamara Beck-Biskup, BSc BA
Titel: Cholin in der Ernährung von heute: Eine quantitative Erhebung der alimentären
Cholinzufuhr von Jugendlichen aus Wiener Schulen
Die Preisarbeit von Tamara Beck-Biskup, BSc BA widmete sich einem in der Praxis häufig übersehenen, aber essenziellen Nährstoff. Cholin ist eine vitaminähnliche Substanz, die als Vorläufermolekül für wichtige Stoffwechselprozesse dient. Ein Mangel kann zu Muskel- und Leberschäden führen, die endogene Synthese ist nicht bedarfsdeckend, und Cholin gilt als essenzieller Nährstoff – im deutschsprachigen Raum fehlen jedoch noch spezifische Leitlinien. Da es noch keine zuverlässigen Laborparameter gibt, sind Ernährungsanamnese und Nährwertberechnung derzeit die besten diagnostischen Methoden.
Im Rahmen einer quantitativen Querschnittstudie mit Online-Ernährungsprotokoll wurden an fünf Schulen 274 Fragebögen ausgefüllt, wovon 171 ausgewertet werden konnten (Altersdurchschnitt: 16,3 Jahre). Das Ergebnis war eindeutig: 86,5 % der Jugendlichen erreichten den AI-Wert der EFSA nicht – ein Befund, der den internationalen Statistiken (50–90 % Unterversorgung) entspricht. Eier spielten mit 50–60 % des zugeführten Cholins eine zentrale Rolle. Bei Verzicht auf Eier und Fleisch ist das Risiko einer Unterversorgung deutlich erhöht. Die Arbeit empfiehlt eine Aktualisierung von Ernährungsunterlagen, insbesondere für VegetarierInnen, VeganerInnen sowie Schwangere.
Preis WISSENSCHAFT & FORSCHUNG
GewinnerInnen: Manuela Hatz, MEd und Team
Titel: Gesundheitliche Chancengerechtigkeit und Empowerment durch kostenlose
individualisierte Ernährungsberatung für sozioökonomisch benachteiligte
SteirerInnen
Die Arbeit von Manuela Hatz, MEd und Team widmete sich einer strukturellen Versorgungslücke an der Schnittstelle von Armut und Ernährungsgesundheit. Sozioökonomisch benachteiligte Bevölkerungsgruppen sind überdurchschnittlich häufig von Übergewicht und Adipositas betroffen – und haben gleichzeitig den schlechtesten Zugang zu qualitätsgesicherter Ernährungsberatung. Das steiermarkweite Programm „Gemeinsam g’sund genießen“ setzt hier an: Seit 2018 vom Gesundheitsfonds Steiermark finanziert und vom Institut Diätologie der FH JOANNEUM umgesetzt, bietet es kostenfreie, individualisierte Ernährungsberatung in den steirischen Bezirken.
Die Ergebnisse belegen sowohl eine sehr gute Zielgruppenerreichung als auch eine hohe Wirksamkeit: Von 2018 bis 2025 wurden 3.167 Personen in über 11.000 Beratungsstunden betreut. 64,2 % der KlientInnen verfügen über einen Lehr- oder Pflichtschulabschluss, 17,7 % sind von der Rezeptgebühr befreit – beide Werte liegen deutlich über dem steirischen Bevölkerungsdurchschnitt. 84,3 % der KlientInnen bewerteten ihre individuell vereinbarten Behandlungsziele als erreicht. Ergänzend stärkt das Programm durch strukturierte Rückmeldungen an Ärztinnen und Ärzte sowie aktive Vernetzung mit anderen Gesundheitsberufen die interprofessionelle Versorgung in der Region – und leistet damit einen nachhaltigen Beitrag zur langfristigen Verankerung diätologischer Leistungen im extramuralen Bereich.
Preis INNOVATIVE DIÄTLOGISCHE PRAXIS
GewinnerInnen: Carina Eckhardt, MSc und Team
Titel: Der digitale Ernährungsbegleiter – für eine bessere ernährungstherapeutische
Versorgung onkologischer PatientInnen
Die gemeinnützige Vereinigung „Eat What You Need“ – unter der Leitung von Carina Eckhardt, MSc und Team – betreibt die Plattformen was-essen-bei-krebs.de und was-essen-kinder-bei-krebs.de. Neu ist ein digitaler Ernährungsbegleiter, über den NutzerInnen regelmäßig Formulare ausfüllen und dafür individuelle Tipps erhalten. Das System warnt bei kritischem Gewichtsverlauf, informiert über Eiweißbedarf und fragt aktuelle Beschwerden ab – alles Informationen, die sonst aufwändig in der Anamnese erhoben werden müssen. KrebspatientInnen können optional über die Plattform mit DiätologInnen vernetzt werden. Die Plattform begleitet durch alle Phasen der Krebsbehandlung von der Diagnose über Chemotherapie und Operation bis zur krebsfreien bzw. palliativen Situation und soll künftig bereits bei der Diagnosestellung eingesetzt werden.
HAUPTSITZUNG 1 | Von physiologischen Grundlagen zu praxisrelevanten Empfehlungen
Klein, aber essenziell – Grundlagen Mikronährstoffe

Prof. Dr. med. Cem Ekmekcioglu eröffnete die erste Hauptsitzung mit einem umfassenden Überblick über die Funktionen, Bedarfswerte, Statuserhebung und klinische Relevanz von Mikronährstoffen. Besonderes Augenmerk legte er auf ihre Rolle im Immunsystem, die die COVID-19-Pandemie nachdrücklich in den Fokus gerückt hatte. Zink, Selen, Vitamin D und Vitamin C wirken antiinflammatorisch und antioxidativ – wobei die Evidenzlage für Vitamin C und Selen noch vergleichsweise dünn ist. Für Vitamin D gilt: ein Mangel sollte unbedingt vermieden werden. (Weiterlesen …)
Eine wichtige methodische Einschränkung betonte der Referent ausdrücklich: Bei der Statuserhebung muss stets der Entzündungswert berücksichtigt werden, da erhöhte Entzündungsmarker die Plasmaspiegel von Zink und Selen verfälschen. Ähnliches gilt für Eisen, wo Hepcidin als Regulator der Fe-Homöostase eine zentrale Rolle spielt und bei Entzündungen das Ferritin ansteigen lässt. Österreich zählt zu den Jod-Mangelländern, weshalb dieser Wert regelmäßig überprüft werden sollte. Für Vitamin D empfahl der Vortragende auf Basis einer eigenen Publikation einen Spiegel zwischen 70 und 80 nmol/l als praktikablen Zielwert.
Zu Nahrungsergänzungsmitteln nahm er eine differenzierte Position ein: Klare Indikationen bestehen für Vitamin B12 bei veganer Ernährung, Folsäure bei Kinderwunsch, Jod in der Schwangerschaft und Eisen bei diagnostiziertem Mangel. Überdosierungen – insbesondere bei Vitamin D – können klinisch relevant werden, wie ein Fallbeispiel mit Nierensklerosierung verdeutlichte. Bei PatientInnen mit Leber- oder Nierenerkrankungen ist besondere Vorsicht geboten.
Neue Ernährungsempfehlungen mit besonderem Fokus auf Mikronährstoffzufuhr

Univ.-Prof. Mag. Dr. Karl-Heinz Wagner präsentierte den aktuellen Stand der D-A-CH-Referenzwerte und erläuterte, wie evidenzbasierte Ernährungsempfehlungen entstehen. 2025 wurden neue Referenzwerte für Jod (150 µg/Tag, zuvor 200 µg) und Vitamin E (8 mg/Tag) verabschiedet. Erstmals gibt es nun auch offizielle österreichische Empfehlungen für eine ovo-lakto-vegetarische Ernährungsweise neben den omnivoren Empfehlungen. (Weiterlesen …)
Methodisch setzt die Modellierung auf Entscheidungsvariablen wie Verzehr, Nährstoffzusammensetzung, Umwelteinfluss und Krankheitslast. Neu ist die explizite Integration von Klimawandel und Biodiversitätsverlust im Sinne der Planetary Health Diet. Beide Ernährungsmodelle (omnivor und vegetarisch) zeigen die größten Abweichungen von der Realität bei Kalzium, Zink, Eisen und Vitamin B12. Positiv hervorgehoben wurde die erstmalige Aufnahme von Hülsenfrüchten als eigene Kategorie – der tatsächliche Konsum in Österreich sei nach wie vor sehr gering. Die Methode der mathematischen Optimierung sei transparent und reproduzierbar, ersetze jedoch nicht die ExpertInnen-Meinung.
Vorteile und Herausforderungen von bioaktiven Pflanzenstoffen zur Steigerung der menschlichen Gesundheit

FH-Prof. Priv.-Doz. Dr. Julian Weghuber von der FH Oberösterreich führte in die Welt der sekundären Pflanzenstoffe ein: Von weltweit rund 28.000 Pflanzenarten mit potenziell gesundheitsfördernden Wirkstoffen ist nur ein kleiner Teil wissenschaftlich gut belegt. Ihr Potenzial ist enorm – 60–70 % aller bioaktiven Substanzen in pharmazeutischen Produkten (Aspirin, Taxol, Morphin) gehen auf Pflanzenstoffe zurück. (Weiterlesen …)
Zentrale Limitierungen seien die oft unzureichende Bioverfügbarkeit, die starke interindividuelle Variabilität der Wirkung sowie die Studienheterogenität. Ein Forschungsschwerpunkt der Gruppe liegt auf Fermentation als Methode zur Verbesserung der Bioverfügbarkeit: Durch gezielte Fermentation können Zuckerverbindungen abgebaut werden, die im Darm schlecht absorbiert werden. Als vielversprechendes Anwendungsfeld präsentierte Weghuber Pflanzenstoffe zur Diabetesprävention: Bestimmte Extrakte inhibieren den Glukose-Transporter GLUT5 und konnten Glukosespitzen beim Menschen messbar reduzieren.
EU-Höchstmengen von Nährstoffen in Nahrungsergänzungsmitteln und angereicherten Lebensmitteln

Mag. Markus Zsivkovits gab einen Überblick über den aktuellen europäischen Rechtsrahmen für Vitamine und Mineralstoffe in Nahrungsergänzungsmitteln und angereicherten Lebensmitteln. Das europäische Lebensmittelrecht hat sich im Laufe der Zeit von 339 auf 1.165 Seiten ausgeweitet. (Weiterlesen …)
Vitaminzusätze sind freiwillig, unterliegen aber Höchstmengenregelungen – insgesamt stehen 13 Vitamine und 17 Mineralstoffe auf der offiziellen Liste. Einige Substanzen wie Laetril (Vitamin B17, tatsächlich eine Form von Blausäure), Vanadium und Lithium sind im EU-Raum für Nahrungsergänzungsmittel nicht zugelassen. Der regulatorische Trend gehe eher in Richtung „Was schadet nicht?“ als „Was braucht man unbedingt?“ – ein Ansatz, den der Referent kritisch kommentierte.
HAUPTSITZUNG 2 | Mikronährstoffe in Prävention und Lebensstilberatung: Diagnostik – Biomarker
Home-Tests aus Laborperspektive unter Berücksichtigung wissenschaftlicher Aspekte

Dejan Milosavljevic, MSc widmete sich einem in der Praxis zunehmend relevanten Phänomen: der unkritischen Nutzung von Selbsttests im Ernährungs- und Lifestyle-Bereich. DNA-Tests, Mikronährstoff-Tests und Mikrobiomanalysen beeinflussen Ernährungsentscheidungen oft ohne fachliche Unterstützung. Anhand von Fallbeispielen – einer Frau mit Magnesiummangel-Verdacht und einem Patienten mit vermeintlicher Dysbiose – zeigte er auf, wie fehlgeleitete Self-Tests zu ungeeigneten Maßnahmen führen können. (Weiterlesen …)
Die größte Fehlerquelle liegt in der Präanalytik: Weltweit sind 98,4 % von Laborfehlern auf präanalytische Mängel zurückzuführen (Hämolyse, Lipämie). Bei professionellen Labors werden über 85 % dieser Fehler vor Befundfreigabe korrigiert – bei Home-Tests, die von Laien durchgeführt werden, fehlt diese Kontrollinstanz. Die Folge: 40–50 % falsche Befunde. Problematisch sind zudem Transport und Lagerung, fehlende Nüchternwerte und mangelnde Standardisierung. Abschließend verwies Milosavljevic auf offene Datenschutzfragen bei der Speicherung genetischer Daten.
Nährstoffdiagnostik und was evidenzbasierte Parameter wirklich aussagen

Nadja Leditznig, MSc plädierte für einen konsequent kontextbasierten Umgang mit Laborwerten – das Motto: „Es werden PatientInnen behandelt, nicht Zahlen.“ Sie unterschied zwischen Statusmarkern (Ferritin, 25-OH-Vitamin-D), Funktionsmarkern (Transferrinsättigung, Methylmalonsäure) und Surrogatmarkern (LDL-Cholesterin, HbA1c) und betonte, dass ein valider Marker stets validiert, stabil interpretierbar, klinisch relevant und therapiesensitiv sein müsse. (Weiterlesen …)
Einige praxisrelevante Punkte: Vitamin B12 ist die häufigste Fehldiagnose in der Praxis – Holo-TC gilt als empfindlichster Frühmarker, Methylmalonsäure steigt bei zellulärem Mangel früh und zuverlässig. Gesamt-B12 ist hingegen unzuverlässig. Bei Eisen ist Ferritin nur in Kombination mit CRP aussagekräftig; hier empfahl die Vortragende den Thomas-Plot als diagnostisches Instrument zur Differenzierung von klassischem, funktionellem und entzündungsassoziiertem Eisenmangel. Serum-Magnesium und Serum-Zink sind stark schwankend und damit von eingeschränktem diagnostischem Wert – die Ernährungsanamnese und klinische Beobachtung sind hier wichtiger als Einzelwerte. Ihr Fazit: Referenzbereich ist nicht gleich Zielbereich, und ein Laborwert ist niemals absolut.
Mikrobiomanalyse – zwischen Hype und Wirklichkeit
Madeline Bartsch, MSc eröffnete ihren Vortrag mit einem Fallbeispiel: Eine Klientin bringt einen 12-seitigen kommerziellen Mikrobiombefund mit – die entscheidende Frage: Was bedeutet das für die Beratungspraxis? Sie zog eine klare Trennlinie zwischen wissenschaftlicher Praxis (Gruppenvergleiche, kontrollierte Studien, Assoziationen) und individueller Anwendung (Befund, Interpretation, Empfehlung) und stellte die Übertragbarkeit beider Ebenen grundsätzlich in Frage. (Weiterlesen …)
Zwar beeinflusst Ernährung das intestinale Mikrobiom reproduzierbar, und mikrobielle Metabolite wie kurzkettige Fettsäuren haben nachweisbare systemische Effekte. Veränderungen im Mikrobiom werden mit Erkrankungen wie Adipositas und CED assoziiert – die Kausalitätsfrage ist jedoch noch offen. Das zentrale Problem kommerzieller Tests: Es gibt keine validierten diagnostischen Cut-offs, keine klinisch geprüften Entscheidungsalgorithmen und keine ausreichende Evidenz für individualisierte Empfehlungen auf Basis einer Einzelanalyse. Tests mit eigenen Referenzwerten geben oft nicht an, worauf diese basieren. Für die Zukunft brauche es standardisierte Präanalytik, longitudinale Designs und große Referenzkohorten. Klinisch vielversprechende Anwendungen sieht Bartsch vor allem beim Monitoring nach Antibiotikatherapie, bei metabolischen Interventionen und als ergänzenden Verlaufsmarker bei CED.
Mikronährstoffe in den verschiedenen Lebensphasen

Prof. Dr. Martin Smollich – auf Instagram als @ErnMedBlog bekannt – präsentierte einen aktuellen, lebensphasenorientierten Überblick über Mikronährstoffe. Zu jedem Lebensabschnitt stellte er neben dem bekannten Stand auch aktuelle Studienergebnisse vor. (Weiterlesen …)
Schwangerschaft/Stillzeit: Klassische Empfehlungen für Folsäure, Jod, Eisen, Vitamin D und Omega-3 bleiben bestehen. Eine neue Metaanalyse über 11 RCTs zeigte, dass aktivierte Folsäure (MTHF) trotz höherer Folatspiegel keine klinische Überlegenheit gegenüber synthetischer Folsäure aufweist – unabhängig vom MTHFR-Genotyp.
Kindheit/Jugend: Vitamin D zur Prävention kindlicher Atemwegsinfekte zeigte in einer Metaanalyse über 17 RCTs (n = 18.372) keinen Effekt auf Dauer und Symptomschwere, kann aber dosisabhängig die Inzidenz senken – tägliche Gabe ist wirksamer als Bolus-Gaben. Bei ADHS zeigte eine Metaanalyse über 10 RCTs einen signifikanten Effekt von Vitamin-D-Supplementation auf Impulsivität und Konzentration.
Mittleres Lebensalter: Eine aktuelle Studie zur Einnahmefrequenz von Eisen bestätigte, dass orale Eisenzufuhr über 60 mg Hepcidin induziert und die Resorption senkt. Bei schlechter gastrointestinaler Verträglichkeit kann die 2-tägliche Gabe empfohlen werden.
Perimenopause: Kreatin rückt als vielversprechende Substanz für Frauen ab 50 in den Vordergrund. Eine Studie zeigte, dass Kreatin-HCl (1.500 mg/d) über 8 Wochen die Reaktionszeit verbesserte, LDL-C senkte und Stimmungsschwankungen reduzierte.
Höheres Alter: Lithiumorotat als Mikronährstoff für die Demenzprävention ist interessant, aber noch experimentell (in der EU als NEM verboten). Besonders bemerkenswert: Die COSMOS-Metaanalyse zeigt, dass tägliche Multivitamineinnahme bei älteren Erwachsenen einen kognitiven Effekt hat, der einem rund zwei Jahre jüngeren Gehirn entspricht – wobei Smollich betonte, dass dies Mangelsymptome ausgleicht, aber den Alterungsprozess nicht bremst.
HAUPTSITZUNG 3 | Food First
Wie funktioniert der NutriScore? Algorithmus und aktueller Stand der Wissenschaft

Mag.a Judith Benedics erläuterte Konzept, Entstehungsgeschichte und aktuellen Stand des NutriScore als Front-of-Pack-Label. Das ursprünglich in Frankreich entwickelte Label ist eine eingetragene Marke beim EUIPO und wird von einem Steuerungs- und einem wissenschaftlichen Gremium begleitet. Ziel ist die Vergleichbarkeit von Lebensmitteln nach ernährungsphysiologischen Gesichtspunkten am Point of Sale – dabei soll die gesündere Wahl zur leichteren werden. (Weiterlesen …)
Der neue Algorithmus bringt relevante Anpassungen: strengere Bewertung von Zucker und Salz, höhere Schwellenwerte für Ballaststoffe und Protein, Nüsse/Samen/pflanzliche Öle als eigene Kategorie sowie eine einheitlichere Bewertung von Getränken und Süßstoffen. Österreich ist von einer verpflichtenden Einführung noch weit entfernt, aber evidenzbasierte Wirksamkeitsstudien liegen zahlreich vor. Lebensmittel wie Olivenöl stoßen aufgrund ihres Fettgehalts an die Grenzen des Algorithmus – eine bekannte Limitation des Systems.
Sauer macht NICHT nur lustig! Fermentation – wenn Säure Lebensmittel veredelt statt verdirbt

Martin Leitner zeichnete ein lebendiges Bild der Fermentation: eine seit 6.000–8.000 Jahren praktizierte Methode, die weit mehr ist als bloße Konservierung. Heute steht Fermentation für mikrobielle Umwandlung von Lebensmitteln mit positiven Effekten auf Mikrobiom, bioaktive Stoffe und Sensorik. (Weiterlesen …)
Neben der klassischen Milchsäuregärung und Mischfermentation thematisierte er alkalische Fermentation sowie das Potenzial für die Gemeinschaftsverpflegung: geringe Investition bei hohem sensorischem Gewinn, Vermeidung von Lebensmittelabfällen und Nutzung von Gemüseresten.
Geschmacklich verstärkt Fermentation Umami, Sauer und Salzig, während Süß, Bitter und Fettgeschmack reduziert werden. Fermentierte Produkte können zudem bestimmte Mikronährstoffe – etwa Vitamin B12 – für VeganerInnen zugänglich machen. Aktuelle Trends: DIY-Fermentation, pflanzenbasierte Fermente (Getränke, Würzsaucen) und Postbiotika.
Wirkstoffwunder Pilz: Bioaktive Substanzen zwischen Nahrung und Medizin

Michaela Friedl öffnete das Fenster zu einem botanisch eigenständigen Reich: Von geschätzten 2,2–3,8 Milliarden Pilzarten sind erst 130.000 katalogisiert, in Österreich gibt es rund 17.000 Arten, von denen 120–200 essbar sind. Speisepilze sind energiearm, ballaststoffreich und liefern eine gute Proteinqualität mit essentiellen Aminosäuren sowie Vitamine und Mineralstoffe – allerdings sind sie als B12-Quelle für die vegane Ernährung nicht relevant. (Weiterlesen …)
Besonderes Interesse weckte ein praktischer Tipp: Pilze mit Lamellen nach oben 30–120 Minuten in die Sonne legen steigert den Vitamin-D-Gehalt um ein Vielfaches – und dieser bleibt auch beim Kochen oder Braten erhalten. Zu den bioaktiven Substanzen zählen Polysaccharide (Beta-Glucane mit antikanzerogenen Eigenschaften und positiver Wirkung auf Blutzucker und Cholesterin), Ergothionein, Lovastatin und Psilocybin. Speziell eingegangen wurde auf Reishi (Anti-Ageing), Maitake (Menopause), Chaga (Immunsystem) und Eichhase (entwässernde Wirkung ohne Kaliumverlust). Den Begriff „Vitalpilz“ bezeichnete die Vortragende als reinen Marketingbegriff. Zur Mykotherapie nahm sie eine kritisch-distanzierte Haltung ein: Die Anwendung von Pilzextrakten in Europa bewege sich im Bereich von Nahrungsergänzungsmitteln, die Qualität von Pilzpulver-Präparaten variiere erheblich.
Fachtagung Ergotherapie Austria – Fokus Chancengerechtigkeit
Unter dem Titel „Fokus Chancengerechtigkeit – ergotherapeutische Perspektiven: Handeln zwischen Ideal und Realität“ lud Ergotherapie Austria am 20. und 21. März 2026 ins Austria Trend Hotel Savoyen in Wien. Im Mittelpunkt stand ein Thema, das weit über den therapeutischen Alltag hinausreicht: Wie lässt sich Chancengerechtigkeit – also nicht bloß gleiche Ausgangsbedingungen für alle, sondern faire Chancen trotz unterschiedlicher Lebensrealitäten – konkret in der Ergotherapie verankern und umsetzen?
Verbandspräsidentin Marion Hackl betonte, dass das Prinzip der Chancengerechtigkeit ein essenzieller Bestandteil ergotherapeutischen Denkens und Handelns sei – und zwar nicht nur in der direkten Arbeit mit PatientInnen: Ergotherapeutische Fachkräfte übernähmen auch die Rolle von Gesundheitsfürsprecherinnen und -fürsprechern, die in Institutionen und sozialen Systemen aktiv für Teilhabe eintreten und Barrieren benennen. Als besonders zukunftsweisendes Modell hob sie die kindergarten- und schulbasierte Ergotherapie hervor, die es ermöglicht, direkt im Lebensalltag von Kindern einen Beitrag zu chancengerechtem Aufwachsen zu leisten.
Das Programm vereinte Keynotes, Workshops und Diskussionen: Dr. Sabine Haas von der Gesundheit Österreich GmbH eröffnete die Tagung mit einem Blick auf die systemischen Voraussetzungen, damit im Gesundheitssystem niemand zurückgelassen wird. Sozialexperte Mag. Martin Schenk von der Diakonie Österreich sprach über die gesundheitlichen Folgen von Armut und Ohnmachtserfahrungen. ORF-Nahost-Korrespondent Karim El-Gawhary weitete den Blick auf globale Ungleichheiten und die Frage, welche Verantwortung sich daraus für internationale Zusammenarbeit und Professionen ergibt.
Gesundheitliche Chancengerechtigkeit – Grundlagen, Daten und Handlungsfelder

Der Eröffnungsvortrag der Fachtagung von Mag. Dr. Sabine Haas (GÖG) widmete sich einem strukturellen Thema, das für die ergotherapeutische Praxis ebenso relevant ist wie für die gesamte Gesundheitspolitik: der gesundheitlichen Chancengerechtigkeit. (Weiterlesen …)
Begriffliche Grundlage
Die Referentin differenzierte zu Beginn präzise zwischen gesundheitlicher Ungleichheit und gesundheitlicher Ungerechtigkeit. Nicht jede Ungleichheit sei ungerecht – Kinder haben nun einmal andere Gesundheitsbedarfe als ältere Menschen. Ungerechtigkeit entstehe dort, wo Menschen bei grundsätzlich gleichen Voraussetzungen dennoch zu ungleichen Gesundheitschancen kämen. Besonders betont wurde, dass Menschen mit biologisch bedingten Beeinträchtigungen, Behinderungen oder Entwicklungsstörungen gezielt Ressourcen benötigen, um soziale Teilhabe zu ermöglichen – auch das sei ein Kerngehalt von Chancengerechtigkeit.
Datenlage für Österreich
Anhand der österreichischen Gesundheitsbefragung (Statistik Austria, alle fünf Jahre) sowie der Studie „Soziale Krisen-Folgen“ (im Auftrag des Sozialministeriums) zeigte die Referentin eindrücklich, wie stark Bildung und Einkommensebene den selbst eingeschätzten Gesundheitszustand, chronische Erkrankungen wie Diabetes und Depression sowie Rückenbeschwerden beeinflussen. Die Daten belegen ein ausgeprägtes soziales Gesundheitsgefälle – keinen einfachen Bruch zwischen einer benachteiligten Gruppe und dem Rest, sondern einen stufenweisen Verlauf durch alle Einkommens- und Bildungsschichten. Besonders alarmierend: Zwischen 2014 und 2019 hat sich diese Schere nochmals um rund 10 % vergrößert – bei Frauen stärker als bei Männern.
Krisen als Verstärker
Aktuelle Krisen – COVID-19-Pandemie und Inflation wurden exemplarisch behandelt – verschärfen bestehende Ungleichheiten systematisch: Benachteiligte Gruppen sind stärker exponiert, stärker betroffen und verfügen über weniger Schutz- und Kompensationsressourcen. Bei der Pandemie zeigte sich dies an der unterschiedlichen Möglichkeit zur Telearbeit, an Wohnsituation und Überfüllung sowie an Clustern in Schlachthöfen oder Flüchtlingsunterkünften. Bei der Inflation trifft die strukturell höhere Teuerung bei Grundbedarfsgütern (Lebensmittel, Energie) genau jene, die 60–70 % ihres verfügbaren Einkommens dafür aufwenden müssen. Folgen sind Ernährungsarmut, Energiearmut, Hygienearmut und eingeschränkte soziale Teilhabe. Eine Erhebung in Kooperation mit der Volkshilfe (Winter 2023) unter armutsbetroffenen Familien bestätigte: Über 70 % nannten steigende Lebensmittelkosten als zentrale Belastung, die Hälfte schränkte Freizeitaktivitäten, Kleidung und Essen ein.
Lebenslaufperspektive
Die Referentin betonte die Bedeutung der sogenannten Life-Course-Perspektive: Gesundheit ist das Ergebnis eines lebenslangen Prozesses, der bereits vor der Geburt – in der Schwangerschaft und in den ersten 1.000 Tagen – entscheidend geprägt wird. Langzeitstudien über 50 Jahre belegen, dass die sozioökonomische Lage in der Kindheit das Risiko für Herzerkrankungen im Alter von 60 Jahren beeinflusst – selbst wenn sozialer Aufstieg gelingt. Gesundheitliche Ungleichheiten zeigen sich bereits im Kindes- und Jugendalter: In einer Erhebung mit niederösterreichischen Ärztinnen und Ärzten beobachteten 85 % der Kinderärztinnen und -ärzte gesundheitliche Beeinträchtigungen bei Kindern aus sozioökonomisch benachteiligten Verhältnissen, die sie auf psychosomatische Folgen der Armutslage zurückführten.
Erklärungsmodell und gesellschaftliche Kosten
Als Erklärungsrahmen stellte die Referentin ein Modell vor, das soziale Ungleichheit (Unterschiede in Macht, Geld und Prestige) über differentielle Belastungen, Bewältigungsressourcen und Gesundheitsversorgung mit gesundheitlicher Ungleichheit verbindet. Diese Ungleichheit hat sowohl individuelle als auch gesellschaftliche und ökonomische Kosten – und sie wird von Generation zu Generation weitergegeben. Die geringe soziale Mobilität in Österreich sei hierfür ein klarer Beleg.
Strategien und historische Beispiele
Für Gegenmaßnahmen skizzierte die Referentin zwei grundlegende Strategien: zielgruppenspezifische Maßnahmen für besonders benachteiligte Gruppen einerseits und universelle Ansätze, die allen zugutekommen, andererseits – wobei letztere weniger stigmatisierend wirken und gesellschaftliche Akzeptanz fördern. Als historische Inspirationsquellen nannte sie das Rote Wien der Zwischenkriegszeit (Mindestlohn, Verbot der Kinderarbeit, sozialer Wohnbau, Kindergärten, Bekämpfung der Tuberkulose durch Hausbesuche und gestreute Gemeindebauten als Instrument gegen Segregation) sowie die Sozialversicherungsreformen der frühen Republik. Aktuelle Ansätze verbinden Gesundheits-, Sozial- und Klimaagenda – etwa durch gemeinnützigen Wohnbau mit Energieeffizienz und Grünraumzugang.
Relevanz für die Ergotherapie
Den Abschluss bildete ein klarer Appell an die ergotherapeutische Profession: Sie ist durch ihren direkten Kontakt zu Familien in einer Schlüsselposition – aufmerksam zu machen, auf Barrieren hinzuweisen und Angebote entsprechend anzupassen. Frühe Hilfen und niederschwellige Versorgungsangebote erreichen sozioökonomisch benachteiligte Familien überproportional – ein Auftrag, den die Profession aktiv gestalten kann. Der abschließende Befund war nüchtern, aber eindeutig: Österreich verfügt über eine gute Ausgangsbasis, aber gesundheitliche Ungleichheiten bestehen fort und verstärken sich – und das brauche eine gesamtgesellschaftliche Antwort, zu der die Ergotherapie ihren Beitrag leisten kann und soll.
Geschlechtergerechtigkeit und berufspolitische Perspektiven in der Ergotherapie

Der Vortrag von Barbara Bachmann, BSc, MSc widmete sich der Frage, wie stark die Ergotherapie historisch und gegenwärtig durch Geschlechterverhältnisse geprägt ist – und welche Konsequenzen sich daraus für Professionalisierung, berufspolitische Entwicklung und Versorgungsgerechtigkeit ergeben. Ausgangspunkt war die zentrale These, dass viele aktuelle Herausforderungen der Berufsgruppe ohne eine geschlechterkritische Perspektive nicht vollständig verstanden werden können. (Weiterlesen …)
Historische Entwicklung und geschlechtsspezifische Prägung
Ein historischer Rückblick – mit Fokus auf die Entwicklung der Ergotherapie in den USA – zeigte, dass die Profession eng mit frühen Frauenbewegungen verknüpft ist. Frauen erhielten über Tätigkeiten im sozialen und therapeutischen Bereich erstmals Zugang zum Arbeitsmarkt, jedoch unter klar definierten Rollenbildern: Fürsorglichkeit, Anpassungsfähigkeit und Selbstaufopferung galten als zentrale Eigenschaften. Gleichzeitig wurde die Ergotherapie von Beginn an in eine ärztlich dominierte Struktur eingebettet, was ihre Autonomie bis heute beeinflusst. Auch im Kontext der Weltkriege wurde die Profession funktionalisiert, etwa zur Wiederherstellung der Arbeitsfähigkeit von Soldaten – eng verknüpft mit ökonomischen Interessen.
Ergotherapie als Frauenberuf und strukturelle Ungleichheiten
Die Referentin betonte, dass die Ergotherapie bis heute eine stark feminisierte Berufsgruppe ist (in Österreich etwa 94 % Frauen). Solche „Frauenberufe“ sind strukturell häufig mit geringerer Bezahlung, niedrigeren Kompetenzzuschreibungen, eingeschränkten Karrierewegen und langsamerer Professionalisierung verbunden. Dem gegenüber stehen „Männerberufe“, die tendenziell höher bewertet werden und bessere Arbeitsbedingungen bieten. Dieses Ungleichgewicht sei kein Zufall, sondern Ausdruck historisch gewachsener, patriarchaler Strukturen.
Auswirkungen auf Berufsalltag und Individuen
Auf individueller Ebene zeigen sich diese Strukturen in Form von Rollenbildern, Erwartungshaltungen und ungleichen Chancen. Frauen in der Ergotherapie werden häufiger mit fürsorglichen, organisatorischen oder weniger prestigeträchtigen Aufgaben betraut, während Männer – trotz ihrer Minderheit – oft schneller in Führungspositionen aufsteigen und von höheren Gehältern profitieren. Gleichzeitig erleben männliche Ergotherapeuten häufig Rollenkonflikte oder Stigmatisierung in einem weiblich konnotierten Berufsfeld. Insgesamt beeinflussen geschlechtsspezifische Zuschreibungen sowohl die berufliche Identität als auch die Zusammenarbeit in Teams.
Repräsentation, Kommunikation und Professionalisierung
Ein weiterer Schwerpunkt lag auf der öffentlichen Darstellung der Ergotherapie. Analysen zeigten, dass mediale Repräsentationen häufig stereotype Bilder reproduzieren und damit die Wahrnehmung der Profession mitprägen. Sprache und Kommunikation wurden als zentrale Faktoren hervorgehoben: Wie über Ergotherapie gesprochen wird, beeinflusst maßgeblich ihre gesellschaftliche Position und Anerkennung. Eine bewusste, reflektierte Kommunikation sei daher ein wichtiger Hebel für Professionalisierung.
Geschlechtergerechtigkeit als gesundheitspolitisches Thema
Die Referentin argumentierte, dass Geschlechtergerechtigkeit nicht nur ein internes Thema der Berufsgruppe ist, sondern weitreichende Auswirkungen auf das gesamte Gesundheitssystem hat. Verbesserungen innerhalb der Ergotherapie – etwa in Bezug auf Diversität, Zugang zu Leistungen oder berufliche Gleichstellung – könnten zu einer gerechteren Versorgung, besseren Teilhabechancen für Patient:innen und insgesamt zu mehr sozialer Gerechtigkeit beitragen.
Ausblick und Forderungen
Abschließend wurde ein klarer Appell formuliert: Die Ergotherapie müsse sich ihrer eigenen Geschichte und der damit verbundenen Machtstrukturen bewusst werden, um ihre Zukunft aktiv gestalten zu können. Dazu gehören ein selbstbewussteres berufliches Auftreten, mehr politische Positionierung sowie die Bereitschaft, bestehende Normen zu hinterfragen. Ziel sei eine Profession, die ihr gesellschaftliches Potenzial voll ausschöpft, sich solidarisch organisiert und aktiv für Chancengerechtigkeit eintritt – sowohl innerhalb der Berufsgruppe als auch darüber hinaus.
Non-Profit-Mentoring als Beitrag zu Chancengerechtigkeit in Ausbildung und Praxis

Der Vortrag von Katrin Hofer von younus und Karin Lettner-Hauser MHPE von der FH Oberösterreich stellte ein Kooperationsprojekt zwischen einer Fachhochschule und dem Mentoring-Programm „younus“ vor, das Studierende der Ergotherapie mit Kindern und Familien aus benachteiligten Lebenslagen zusammenbringt. Im Zentrum stand die Frage, wie durch praxisnahe Ausbildung und zivilgesellschaftliches Engagement sowohl die professionelle Entwicklung von Studierenden als auch die Chancengerechtigkeit für Kinder gestärkt werden kann. (Weiterlesen …)
Ausgangspunkt: Soziale Ungleichheit und fehlende Teilhabechancen
Als Ausgangslage wurden strukturelle Ungleichheiten im österreichischen Bildungs- und Sozialsystem skizziert. Bildungserfolg und gesellschaftliche Teilhabe sind stark von sozialen Ressourcen abhängig; Kinder aus benachteiligten Familien erleben früh Nachteile, die sich über den gesamten Lebensverlauf fortsetzen. Genannt wurden unter anderem erhöhte Armutsgefährdung, sprachliche Barrieren beim Schuleintritt sowie psychische Belastungen bei Kindern und Jugendlichen. Gleichzeitig greifen bestehende Unterstützungssysteme oft zu kurz oder sind unzureichend miteinander vernetzt.
Das Mentoring-Programm „younus“
Das Programm setzt genau an dieser Stelle an: Ehrenamtliche MentorInnen – darunter auch Studierende – begleiten über einen Zeitraum von mindestens sechs bis zwölf Monaten jeweils ein Kind oder eine Familie. Im Fokus stehen Beziehungsarbeit, Ressourcenorientierung und die Förderung sozialer Teilhabe. Anders als therapeutische Interventionen zielt das Mentoring nicht auf Behandlung, sondern auf Stärkung von Selbstwirksamkeit, sozialen Kompetenzen und Alltagsbewältigung.
Verknüpfung mit der Ausbildung
Ein zentrales Element des Projekts ist die Integration des Mentorings in das Studium. Studierende können im Rahmen von Lehrveranstaltungen und Praxisanteilen am Programm teilnehmen und werden dabei fachlich begleitet. Sie übernehmen eigenverantwortlich die Organisation der Treffen, gestalten gemeinsame Freizeitaktivitäten und reflektieren ihre Erfahrungen im Rahmen eines begleiteten Praxistransfers. Dadurch wird soziales Engagement unmittelbar mit professionellem Lernen verknüpft.
Lernprozesse und Wirkung auf mehreren Ebenen
Der Vortrag betonte die vielfältigen Effekte des Projekts: Studierende entwickeln eine professionelle Haltung, lernen Verantwortung zu übernehmen und gewinnen Einblicke in Lebensrealitäten außerhalb klassischer Settings. Gleichzeitig profitieren die begleiteten Kinder durch stabile Beziehungen, neue Erfahrungen und verbesserten Zugang zu Ressourcen und gesellschaftlicher Teilhabe. Auch für die beteiligten Organisationen entstehen Synergien, etwa durch neue Perspektiven, stärkere Vernetzung und eine größere Reichweite der Angebote.
Beziehungsarbeit und Nachhaltigkeit
Ein wichtiger Aspekt ist die Gestaltung von Beginn und Ende der Mentoring-Beziehungen. Die Teilnahme ist freiwillig, sowohl für Studierende als auch für Kinder und Familien. Nach Ablauf des vereinbarten Zeitraums besteht die Möglichkeit, die Beziehung weiterzuführen. Erfahrungen zeigen, dass ein Großteil der Tandems über die formale Programmdauer hinaus bestehen bleibt. Gleichzeitig wird ein bewusster und begleiteter Abschluss als wichtige Lernerfahrung verstanden – insbesondere für Kinder, die stabile und wertschätzende Übergänge oft nicht erleben.
Ausblick: Engagement und strukturelle Verankerung
Abschließend wurde das Projekt als Beispiel dafür präsentiert, wie Ergotherapie über klassische Versorgungsstrukturen hinaus wirken kann. Durch Kooperationen mit Bildungseinrichtungen, sozialen Organisationen und Ehrenamtlichen eröffnet sich ein erweitertes Handlungsfeld, das präventiv ansetzt und gesellschaftliche Verantwortung in den Mittelpunkt stellt. Zugleich wurde dazu ermutigt, solche Modelle weiter auszubauen, strukturell zu verankern und damit langfristig zur Verbesserung von Chancengerechtigkeit beizutragen.
Nahostkonflikt, Völkerrecht und europäische Verantwortung

Der Vortrag von Nahost-Experte Karim El-Gawhary brachte thematisch eine andere Perspektive in die Fachtagung. Er beleuchtete die aktuellen Konflikte im Nahen Osten aus geopolitischer und völkerrechtlicher Perspektive und stellte deren unmittelbare Relevanz für Europa in den Mittelpunkt. Ausgangspunkt war die zentrale These, dass Ereignisse in der Region keineswegs „fern“ sind, sondern Europa in mehrfacher Hinsicht direkt betreffen. (Weiterlesen …)
Drei zentrale Verflechtungen: Energie, Migration, Sicherheit
El-Gawhary argumentierte, dass Krisen im Nahen Osten sich vor allem über drei Dimensionen auf Europa auswirken: Energieversorgung, Migration und Sicherheit. Konflikte – insbesondere in ölreichen Regionen – haben direkte Auswirkungen auf Preise und Versorgungslagen. Gleichzeitig können Kriege Fluchtbewegungen auslösen, wie etwa im Kontext des syrischen Bürgerkriegs. Darüber hinaus begünstigen instabile Verhältnisse das Entstehen extremistischer Gruppen, deren Aktivitäten wiederum sicherheitspolitische Folgen für Europa haben. Daraus leitete er die Vorstellung einer „Schicksalsgemeinschaft“ zwischen Europa und dem Nahen Osten ab.
Völkerrecht unter Druck: Anspruch und Realität
Ein zentraler Teil des Vortrags widmete sich der Frage, ob das internationale Recht tatsächlich universell angewendet wird. El-Gawhary verwies auf die historischen Ursprünge internationaler Gerichtsbarkeit nach dem Zweiten Weltkrieg und stellte die These auf, dass deren Glaubwürdigkeit aktuell auf dem Spiel steht. Anhand des Gaza-Konflikts diskutierte er laufende Verfahren vor internationalen Gerichten – darunter eine Klage wegen möglicher Völkermordhandlungen sowie Haftbefehle wegen mutmaßlicher Kriegsverbrechen. Entscheidend sei dabei weniger die konkrete juristische Bewertung als die grundsätzliche Frage: Gilt das Völkerrecht für alle gleichermaßen oder wird es selektiv angewendet?
Der israelisch-palästinensische Konflikt als strukturelles Problem
Im Zentrum seiner Analyse stand der israelisch-palästinensische Konflikt, den El-Gawhary als strukturell geprägt beschrieb. Er betonte, dass viele aktuelle Dynamiken – Gewalt, Radikalisierung, politische Blockaden – eng mit der fortdauernden Besatzung und deren Auswirkungen verknüpft seien. Entwicklungen wie der fortschreitende Siedlungsbau, territoriale Fragmentierung und Vertreibungen erschwerten eine politische Lösung zunehmend. Gleichzeitig werde die Debatte oft verkürzt geführt, etwa durch die Fokussierung auf einzelne Ereignisse statt auf langfristige Ursachen.
Vier mögliche Zukunftsszenarien
Der Referent skizzierte vier denkbare Entwicklungspfade für den Konflikt:
- Fortsetzung des Status quo, der jedoch als instabil und konfliktanfällig gilt.
- Vertreibung der palästinensischen Bevölkerung, die völkerrechtlich problematisch und politisch kaum umsetzbar wäre.
- Zwei-Staaten-Lösung, die international weiterhin als Referenzmodell gilt, jedoch durch die Realität vor Ort zunehmend erschwert wird.
- Ein-Staat-Lösung mit gleichen Rechten für alle – ein Konzept, das vor allem in akademischen Debatten diskutiert wird, politisch jedoch derzeit kaum realisierbar erscheint.
Alle Optionen seien mit erheblichen Herausforderungen verbunden, weshalb die Situation aktuell als weitgehend festgefahren beschrieben wurde.
Gesellschaftliche Dynamiken und Radikalisierung
Ein eindringlicher Teil des Vortrags befasste sich mit den psychologischen und gesellschaftlichen Folgen des Konflikts. Gewalt und Besatzung zerstörten nicht nur Infrastruktur, sondern auch „die Köpfe der Menschen“ – sowohl auf Seiten der Betroffenen als auch der Handelnden. Traumatisierung, Angst und Hass würden über Generationen weitergegeben und erschwerten langfristig jede Form von Verständigung.
Europa zwischen Staatsräson und Rechtsanspruch
Abschließend thematisierte El-Gawhary die besondere Rolle Europas, insbesondere Deutschlands und Österreichs. Aus der historischen Verantwortung gegenüber Israel einerseits und dem Bekenntnis zum Völkerrecht andererseits ergebe sich ein Spannungsverhältnis, das aktuell deutlich sichtbar werde. Die entscheidende Frage sei, wie diese beiden Prinzipien miteinander vereinbart werden können, ohne an Glaubwürdigkeit zu verlieren.
Notwendigkeit differenzierter Debatten
Der Vortrag endete mit einem Appell, die Diskussion weg von vereinfachten, polarisierenden Positionen hin zu lösungsorientierten und völkerrechtlich fundierten Ansätzen zu führen. Statt sich auf Schuldzuweisungen zu konzentrieren, müsse stärker die Frage in den Mittelpunkt rücken, wie nachhaltige politische Lösungen aussehen können – sowohl auf internationaler Ebene als auch im gesellschaftlichen Diskurs.
Diskriminierungserfahrungen und Versorgungslücken bei lesbischen Frauen im Gesundheitswesen

Der Vortrag beleuchtete ein bislang wenig erforschtes Themenfeld: die gesundheitliche Versorgung und Diskriminierungserfahrungen von lesbischen Frauen. Ausgangspunkt war die persönliche und berufliche Motivation der Referentin Tanja Di Nicola, sich im Rahmen ihrer Masterarbeit am Beispiel des Projekts queerAltern mit strukturellen Ungleichheiten im Gesundheitssystem auseinanderzusetzen und konkrete Handlungsempfehlungen zu entwickeln. (Weiterlesen …)
Forschungslücke und methodischer Zugang
Die Referentin betonte, dass es bislang nur wenige systematische Untersuchungen zu den spezifischen Erfahrungen von lesbischen Frauen im Gesundheitswesen gibt. Aufbauend auf internationaler Literatur – unter anderem aus der Schweiz – entwickelte sie ein eigenes Forschungsdesign, das auf qualitativen Interviews basiert. Ziel war es, Einblicke in subjektive Erfahrungen zu gewinnen und daraus praxisnahe Empfehlungen abzuleiten.
Erfahrungen von Diskriminierung und Unsichtbarkeit
Die Ergebnisse zeigen, dass viele der befragten Frauen im Kontakt mit dem Gesundheitssystem negative Erfahrungen machen. Diese reichen von subtiler Unsichtbarmachung über mangelnde Sensibilität bis hin zu expliziter Diskriminierung. Häufig fühlen sich Betroffene gezwungen, ihre sexuelle Orientierung zu verbergen oder erleben Unsicherheiten im Umgang mit medizinischem Personal. Gleichzeitig fehlt es oft an geeigneten Informations- und Unterstützungsangeboten.
Strukturelle Defizite im Versorgungssystem
Ein zentrales Problem liegt laut Vortrag in strukturellen Rahmenbedingungen: Gesundheitsangebote sind häufig nicht ausreichend auf die Bedürfnisse sexueller Minderheiten ausgerichtet. Dies betrifft sowohl die Ausbildung von Fachpersonal als auch institutionelle Strukturen wie Pflegeeinrichtungen oder Beratungsstellen. Besonders im Alter verstärken sich diese Herausforderungen, etwa durch fehlende inklusive Angebote in der Langzeitversorgung.
Politische Zielsetzungen und Realität
Die Referentin stellte den politischen Anspruch, Gleichstellung und Chancengerechtigkeit im Gesundheitswesen zu fördern, der tatsächlichen Versorgungssituation gegenüber. Zwar existieren entsprechende Strategien und Programme, deren Umsetzung bleibe jedoch oft unzureichend. Es klaffe eine deutliche Lücke zwischen politischen Zielsetzungen und der gelebten Praxis.
Ansätze zur Verbesserung: Sensibilisierung und Qualifizierung
Als zentrale Handlungsempfehlung wurde die gezielte Sensibilisierung von Gesundheitsfachkräften hervorgehoben. Dazu gehören Fort- und Weiterbildungsangebote, die auf die Bedürfnisse von LGBTQ+-Personen eingehen, sowie die Entwicklung inklusiver Leitlinien und Strukturen. Ein im Vortrag vorgestellter Ansatz ist die Qualifizierung von sogenannten „Multiplikator:innen“, die Wissen in ihre jeweiligen Arbeitsfelder tragen und Veränderungen anstoßen können.
Bedeutung von Netzwerken und interdisziplinärer Zusammenarbeit
Darüber hinaus wurde die Bedeutung von Kooperationen zwischen verschiedenen Berufsgruppen und Organisationen betont. Nur durch vernetzte Ansätze könne es gelingen, strukturelle Barrieren abzubauen und nachhaltige Verbesserungen zu erzielen. Projekte in diesem Bereich seien jedoch häufig von begrenzten Ressourcen abhängig und erforderten langfristige Unterstützung.
Abschließend plädierte die Referentin dafür, das Thema stärker in Forschung, Ausbildung und Praxis zu verankern. Die Auseinandersetzung mit Diskriminierung im Gesundheitswesen sei nicht nur eine Frage der Gleichstellung, sondern auch eine Voraussetzung für qualitativ hochwertige Versorgung. Ziel müsse ein inklusives Gesundheitssystem sein, in dem alle Menschen – unabhängig von ihrer sexuellen Orientierung – gleichberechtigt und respektvoll behandelt werden.
16. Tagung der Österreichischen Gesellschaft für Psychologie (ÖGP)
Die 16. Jahrestagung der Österreichischen Gesellschaft für Psychologie fand von 9. bis 11. April 2026 an der Paris-Lodron-Universität Salzburg statt – passenderweise im Jahr des 60-jährigen Jubiläums des dortigen Fachbereichs Psychologie. Die Tagung versteht sich als zentrale Plattform für Forschungsaustausch und Vernetzung wissenschaftlich tätiger Psychologinnen und Psychologen auf nationaler und internationaler Ebene. Vorträge, Podiumsdiskussionen und Postersessions gaben einen breiten Überblick über aktuelle Entwicklungen in der psychologischen Forschung – darunter auch das zunehmend drängende Feld der KI-gestützten psychologischen Versorgung sowie klinische Schwerpunkte wie die männerspezifische Behandlung von Depressionen.
Symposium „Digitale Medien im Kontext von Jugendlichen, Erwachsenen und Familie“

Das Symposium vereinte vier Kurzvorträge rund um die Frage, wie Smartphone- und Social-Media-Nutzung das Leben von Babys, Eltern und Jugendlichen beeinflusst – und beleuchtete dabei bewusst sowohl Risiken als auch Ressourcen. (Weiterlesen …)
VORTRAG 1 | Smartphone-Nutzung und frühe Eltern-Kind-Interaktion
Den Auftakt machte ein Beitrag über die Auswirkungen elterlicher Smartphone-Nutzung auf Säuglinge. Ausgangspunkt waren drei charakteristische Phänomene moderner Smartphone-Nutzung: Technoference (Unterbrechung von Interaktionen durch das Gerät), Absorption (das unbeabsichtigte Versinken im Gerät) und Multitasking (das kaum mögliche parallele Bearbeiten kognitiv anspruchsvoller Aufgaben).
Studien zeigen, dass Eltern am Smartphone seltener auf kindliche Signale reagieren, weniger sprechen, weniger Blickkontakt halten und weniger ko-regulierendes sowie gemeinsam aufmerksames Verhalten zeigen. Bei Kindern lassen sich in der Folge gesteigertes Protestverhalten, risikoreicheres Verhalten zur Aufmerksamkeitsgewinnung und physiologische Stressreaktionen beobachten – Muster, die an das bekannte Still-Face-Paradigma erinnern.
Vorgestellt wurden zwei eigene Laborstudien: die abgeschlossene Studie Smart Baby mit Mutter-Kind-Paaren sowie die laufende Studie Smart Dad mit Vätern. Beide erweitern das klassische Still-Face-Paradigma um eine Smartphone-Phase. Erste Väter-Daten (n=12) deuten auf ähnliche Muster wie bei Müttern hin – mit der interessanten Beobachtung, dass Väter körperlichen Kontakt (Berühren) während der Smartphone-Nutzung möglicherweise sogar steigern, was als Koregulation interpretiert werden könnte. Das Fazit war klar: Smartphones sind aus dem Familienalltag nicht wegzudenken, weshalb die Forschung Wege finden müsse, wie Eltern feinfühlig und gleichzeitig digital präsent sein können.
VORTRAG 2 | Smartphone als Ressource – Elterliches Empowerment
Der zweite Beitrag rückte bewusst die oft vernachlässigte Ressourcenperspektive in den Mittelpunkt. Ausgehend aus qualitativen Studien, in denen Mütter das Smartphone als Quelle sozialer Unterstützung, Kompetenzstärkung und kurzer Selbstfürsorge beschrieben, wurde das Konzept des elterlichen psychologischen Empowerments durch Smartphones entwickelt – verstanden als subjektives Gefühl erweiterter Handlungsmöglichkeiten, theoretisch verankert in der Selbstbestimmungstheorie (Autonomie, Kompetenz, soziale Eingebundenheit).
In einer Längsschnittstudie mit rund 180 Müttern (Experience Sampling über Monat 2 bis 12) zeigte sich auf Tagesebene: Je mehr persönliches Empowerment Mütter berichteten, desto weniger emotionalen Distress erlebten sie. Auf der Ebene der Videobeobachtung von Fütterinteraktionen fanden sich zudem positive Zusammenhänge zwischen berichtetem Empowerment und der Qualität der Mutter-Kind-Interaktion. Einschränkend wurde betont, dass Kausalrichtungen noch ungeklärt sind. Das Ziel der weiteren Forschung: differenzieren, wann Smartphone-Nutzung für Eltern hilfreich ist und wann nicht – um praxisnahe, nicht moralisierende Empfehlungen geben zu können.
VORTRAG 3 | Social Media und Schlafqualität bei Jugendlichen und jungen Erwachsenen
Der dritte Beitrag untersuchte den Zusammenhang zwischen abendlicher Social-Media-Nutzung und Schlafqualität bei 14- bis 25-Jährigen (n=23, Android-Nutzer). Besonderheit der Studie: Neben Selbstauskünften wurden sowohl objektive Schlafdaten (Aktigraphie) als auch objektiv gemessene Smartphone-Nutzung (Tracking-App) über 14 Tage erhoben.
Die Ergebnisse waren differenziert: Objektiv zeigte sich am Wochenende ein signifikanter negativer Effekt höherer Social-Media-Nutzung auf Schlafeffizienz, Schlafdauer und Schlafunterbrechungen. Subjektiv hingegen berichteten die Teilnehmenden an Wochentagen bei längerer Social-Media-Nutzung paradoxerweise eine bessere Schlafqualität – möglicherweise weil Social Media werktags eher als Entspannungs- und Copingstrategie eingesetzt wird, am Wochenende hingegen eher stimulierend und aktiv. Die Diskrepanz zwischen objektiven und subjektiven Schlafmaßen wurde als wichtiger methodischer Befund hervorgehoben, der für zukünftige Studien die Kombination beider Erhebungsformen nahelegt.
VORTRAG 4 | Social Media, psychische Gesundheit und Selbstwert bei Jugendlichen
Den Abschluss bildete eine Masterarbeit aus der Schweiz. Befragt wurden rund 300 Jugendliche und junge Erwachsene (14–25 Jahre) zu ihrer Social-Media-Nutzung, depressiven Symptomen, Körperbild und Selbstwert.
Die meistgenutzten Plattformen waren Instagram und TikTok – wobei TikTok mit durchschnittlich eineinhalb Stunden täglich die längste Verweildauer aufwies. Die Gesamtnutzungszeit lag im Schnitt bei viereinhalb Stunden pro Tag. Rund die Hälfte der Stichprobe berichtete depressive Symptome, knapp ein Viertel negative Konsequenzen durch Social-Media-Nutzung. Als stärkster Risikofaktor für psychische Belastung erwies sich nicht die reine Nutzungsdauer, sondern problematisches Nutzungsverhalten in Verbindung mit dysfunktionaler Emotionsregulation. Als stärkster Schutzfaktor zeigte sich körperliche Aktivität. Die Botschaft der Referentin: Nicht die Zeit am Bildschirm allein ist entscheidend, sondern wie und warum Social Media genutzt wird – ein Plädoyer für einen differenzierteren öffentlichen Diskurs jenseits reiner Bildschirmzeit-Debatten.
Keynote „Männerspezifische Psychotherapie bei Depressionen“

Der Vortrag von Univ.-Prof. Dr. Andreas Walther beleuchtete ein lange vernachlässigtes Feld der klinischen Psychologie: die geschlechtsspezifische Diagnostik und Behandlung von Depressionen bei Männern. (Weiterlesen …)
Epidemiologie und das Dunkelfeld
Ausgangspunkt war die bekannte Prävalenzdiskrepanz: Frauen erhalten deutlich häufiger eine Depressionsdiagnose als Männer. Der Referent argumentierte jedoch, dass diese Zahlen ein erhebliches Dunkelfeld verschleiern. Männer nutzen das Gesundheitssystem generell seltener, die Psychotherapienutzung liegt bei ihnen rund 30–50 % unter jener der Frauen. Ein zentraler Grund: Männer präsentieren Depressionssymptome häufig in externalisierter Form – als Reizbarkeit, Wutausbrüche, feindseliges Verhalten oder Substanzmissbrauch – und werden deshalb oft als aggressiv oder substanzabhängig, nicht aber als depressiv diagnostiziert. Falschdiagnosen und fehlgeleitete Therapien sind die Folge.
Suizid als dramatischer Indikator
Besonders eindringlich thematisierte der Vortrag die Suizidsterblichkeit: Männer sterben in Österreich etwa 3,5-mal häufiger durch Suizid als Frauen, in den USA sogar fünfmal häufiger. Besonders alarmierend: 60 % der Männer, die durch Suizid sterben, hatten in den zwölf Monaten zuvor professionelle Hilfe gesucht – fielen im Anschluss aber dennoch durch das Netz der Versorgung.
Traditionelle Männlichkeitsideologien als Risikofaktor
Ein Schwerpunkt des Vortrags lag auf dem Konzept der traditionellen Maskulinitätsideologien. Diese gesellschaftlich geformten Normen – Eigenständigkeit, emotionale Kontrolle, Dominanz, Risikobereitschaft – erzeugen bei depressiven Männern eine Doppelbelastung: Neben der eigentlichen Symptomatik kämpfen Betroffene mit dem Gefühl, als Mann keine Depression haben zu dürfen. Die Folgen sind Selbststigmatisierung, das Unterdrücken von Hilfesuchverhalten und eine erhöhte Therapieabbruchrate. Eigene Studien zeigten, dass Männer mit hoher Konformität zu diesen Ideologien deutlich schlechtere Therapieergebnisse aufwiesen und häufiger Therapien abbrachen.
Männerspezifische Psychotherapie: Entwicklung und Ergebnisse
Auf dieser Grundlage präsentierte der Referent ein eigens entwickeltes männerspezifisches Therapiekonzept, das auf dem Goldstandard kognitiv-verhaltenstherapeutischer Depressionsbehandlung aufbaut und um folgende Elemente erweitert wurde: eine auf Männer zugeschnittene Psychoedukation (inkl. externalisierender Depressionssymptome), eine Analyse und Bearbeitung von Geschlechtsrollenkonflikten sowie die Reflexion traditioneller Männlichkeitsnormen. Erste Studienergebnisse zeigten, dass diese Psychoedukation bereits nach kurzer Zeit zu einer signifikanten Reduktion von Scham und einer veränderten Symptomwahrnehmung führte – Männer konnten depressive Symptome besser als solche erkennen und benennen.
Testosteron und biologische Wechselwirkungen
Ergänzend wurde der Zusammenhang zwischen Testosteron und Depression beleuchtet. Depressive Männer zeigen häufig niedrigere Testosteronwerte; eine Substitutionstherapie wirkte in Studien vergleichbar mit Antidepressiva, wobei dieser Effekt unabhängig vom Hypogonadismus auftrat.
Der Referent schloss mit einem klaren Plädoyer für weitere, größer angelegte Studien. Die bisherigen Ergebnisse seien vielversprechend – insbesondere zeigten Männer in der männerspezifischen Therapiebedingung eine stärker wachsende therapeutische Allianz –, die Gruppengrößen jedoch noch zu klein für eindeutige Wirksamkeitsnachweise. Die Weiterentwicklung männerspezifischer Psychotherapieangebote bleibt ein erklärtes Forschungsziel.
Keynote „Künstliche Intelligenz und Psychotherapie“

Die Keynote von Prof. Dr. Ramin Assadollahi beleuchtete das rasant wachsende Feld der KI-gestützten psychologischen Unterstützung – mit einem klaren Blick auf Chancen, reale Risiken und gesellschaftliche Verantwortung. (Weiterlesen …)
Ausgangslage: Versorgungslücke als Treiber
Den Rahmen bildete die bekannte Unterversorgung im psychotherapeutischen Bereich: In Deutschland stehen rund 37.000 Psychotherapeutinnen zur Verfügung, während der tatsächliche Bedarf schätzungsweise doppelt so viele Plätze erfordern würde – eine Situation, die sich durch aktuelle Sparmaßnahmen im Gesundheitswesen weiter zuspitzt. Diese Lücke treibe Menschen faktisch zu KI-Systemen: Aktuelle US-Daten aus einer Befragung von 18.000 Personen zeigen, dass rund die Hälfte ChatGPT für psychologische Unterstützung nutzt – 72 % davon bei Angstzuständen oder persönlichen Krisen.
Wie Large Language Models funktionieren – und warum sie therapeutisch relevant sind
Der Referent erläuterte die technischen Grundlagen: Große Sprachmodelle werden auf nahezu allem trainierten digitalen Textmaterial trainiert – darunter Foren, wissenschaftliche Publikationen und Alltagsgespräche. Sie lernen dabei nicht nur Fakten, sondern auch sprachliche Handlungen: wie Menschen in bestimmten Situationen reagieren, Empathie ausdrücken oder argumentieren. Durch gezieltes Prompting – also präzise Instruktionen an das System – lassen sich diese Modelle so konfigurieren, dass sie sich an therapeutischen Prinzipien orientieren. Eine aktuelle Studie zeigte, dass 38 Probandinnen und Probanden in einem Blindtest nicht zuverlässig unterscheiden konnten, ob eine Therapieantwort von einem echten Therapeuten oder einem entsprechend instruierten Sprachmodell stammte.
Sycophancy als systemisches Problem
Ein zentraler Kritikpunkt war die sogenannte Sycophancy aktueller KI-Systeme: die Tendenz, Nutzerinnen und Nutzern systematisch recht zu geben, Widerspruch zu vermeiden und positive Bestätigung zu liefern – da dies die Produktnutzung steigert. Tests an acht großen Modellen zeigten, dass diese Systeme Menschen deutlich häufiger bestätigen als es Menschen in vergleichbaren Situationen tun würden. In therapeutischen Kontexten ist diese Eigenschaft besonders problematisch, da sie dysfunktionale Gedankenmuster verstärken kann.
Suizidalität und der Fall eines 16-Jährigen
Den emotionalen Kern des Vortrags bildete die Analyse eines realen Todesfalls: Ein 16-Jähriger hatte in den Stunden vor seinem Tod intensive Gespräche mit einem KI-System geführt. Trotz früher Hinweise auf suizidale Absichten – die das System durchaus erkannte und zunächst deeskalierend beantwortete – gipfelte der letzte Chat-Eintrag in einer Antwort, die die Suizidabsicht des Jugendlichen implizit bestätigte. Der Fall illustriert die Grenzen aktueller Schutzmechanismen: Diese lassen sich durch gezielte Umgehungsstrategien (etwa durch Umdeutung als Theaterszene) aushebeln. Messungen zeigten, dass es im Schnitt 65 Minuten gezielter Gesprächsführung bedarf, bis ein System vollständige Suizidanleitungen liefert – ein klarer Handlungsbedarf.
Technologische Lösungsansätze
Der Referent skizzierte einen eigenen Forschungsansatz: Reale Therapiegespräche könnten anonymisiert, segmentiert und als strukturierter Dialoggraph aufbereitet werden – ein System, das lernt, wie erfahrene Therapeutinnen und Therapeuten in bestimmten Gesprächssituationen reagieren. Kombiniert mit Technologien zur Erkennung gefährlicher Gesprächsverläufe (etwa von Google, Nvidia oder OpenAI) ließe sich so ein Frühwarnsystem entwickeln, das menschliche Eskalation gezielt auslöst.
Europäische Perspektive und Datensouveränität
Abschließend plädierte der Referent für europäische KI-Lösungen, die lokal betrieben werden, Daten nicht an US-amerikanische Konzerne weitergeben und unter den Anforderungen des EU AI Acts zertifiziert werden. Kulturelle Unterrepräsentation europäischer Daten in bestehenden Modellen – und die damit einhergehenden Verzerrungen – wurden als ernstes, bislang ungelöstes Problem benannt. Sein Fazit war nüchtern: KI-Systeme werden in der psychologischen Versorgung nicht verschwinden – die Frage ist nur, ob sie gesellschaftlich gestaltet oder unkontrolliert überlassen werden.
Symposium „Schadenfreude, Schädlichkeit und Schrecken“

Das Symposium vereinte vier Kurzvorträge rund um die Frage, was Menschen an negativen, schädlichen oder beängstigenden Medieninhalten anzieht – und was das über Persönlichkeit, Kognition und mögliche adaptive Mechanismen verrät. (Weiterlesen …)
VORTRAG 1 | Wer schaut Fail-Videos? Demografie und Persönlichkeit als Prädiktoren
Den Auftakt bildete eine medienpsychologische Untersuchung zur Nutzung von Fail-Videos – jenen im Internet verbreiteten Aufnahmen, in denen Menschen Missgeschicke oder Fehler passieren. Das Phänomen ist keineswegs neu: Bereits in den späten 1980er Jahren wurden vergleichbare Formate im Fernsehen erfolgreich ausgestrahlt.
Auf Basis zweier Studien zeigte sich zunächst ein demografisches Grundmuster: Jüngere Personen und Männer schauen sich häufiger Fail-Videos an als ältere Personen und Frauen – ein Befund, der sich über beide Stichproben hinweg replizieren ließ. Interessanter wurde es bei der Persönlichkeitsanalyse: Als stärkster Prädiktor für intensive Nutzung erwies sich Sadismus, gefolgt von Katagelastizismus (der Freude daran, andere auszulachen) sowie dem sogenannten Fun-War-Stil – einem Humorstil, bei dem Unterhaltung im Vordergrund steht und mögliche Konsequenzen wenig Gewicht haben. Überraschend war ein positiver Zusammenhang mit der Empathiedimension „Personal Distress“: Personen, die bei Missgeschicken anderer selbst Unwohlsein empfinden, schauen sich solche Inhalte offenbar ebenfalls häufiger an – möglicherweise weil ein gewisses Maß an Identifikation erst das emotionale Erleben ermöglicht, das die Inhalte attraktiv macht.
Bemerkenswert war zudem, dass der Geschlechtereffekt bei Einbezug der Persönlichkeitsvariablen verschwand – Männer schauen sich also nicht per se mehr Fail-Videos an, sondern weil sie bestimmte Persönlichkeitsprofile häufiger aufweisen. Der Alterseffekt hingegen blieb bestehen. Motivational lassen sich zwei Haupttypen unterscheiden: Vergnügen aufgrund des Schadens (bei sadistischen Tendenzen) und Vergnügen trotz des Schadens (beim Fun-War-Stil, wo Humor im Vordergrund steht). Studien zeigen zudem, dass das empfundene Vergnügen mit zunehmendem Schweregrad des dargestellten Schadens sinkt – am meisten Unterhaltungswert bieten also harmlos ausgegangene Missgeschicke.
VORTRAG 2 | Gewaltmedienkonsum und malevole Kreativität – eine Tagebuchstudie
Der zweite Beitrag widmete sich der Frage, ob der Konsum von Gewaltmedien – insbesondere True Crime – mit sogenannter malevolenter Kreativität zusammenhängt: dem kreativen Generieren von Ideen, die darauf abzielen, anderen Schaden zuzufügen. Angesichts der enormen Verfügbarkeit von Gewaltinhalten auf Plattformen wie Netflix und der wachsenden Popularität von True-Crime-Formaten ist die Frage gesellschaftlich hochrelevant, auch wenn die Forschung dazu noch in den Anfängen steckt.
In einer ersten Querschnittstudie zeigte sich, dass Horror-Fans tatsächlich schädlichere Ideen in einem Kreativitätstest generierten als andere Personen. Für True-Crime-Fans hingegen fand sich kein schädlicherer, sondern lediglich ein quantitativ reichhaltigerer Output – sie nannten mehr Ideen, nicht schädlichere. Eine anschließende Tagebuchstudie über sieben Tage mit 136 Personen untersuchte den zeitlichen Zusammenhang zwischen Medienkonsum und Affekt: Ängstlichkeit an einem Tag sagte den Konsum von gewalthaltigem True Crime am Folgetag vorher – und umgekehrt sagte True-Crime-Konsum vor dem Schlafengehen Ängstlichkeit am nächsten Morgen vorher. Interessanterweise fand sich auch ein positiver Effekt: Gewalthaltiger True-Crime-Konsum sagte mehr positiven Affekt am Folgetag voraus.
In einer weiteren Tagebuchstudie mit Fokus auf malevolenter Kreativität im Alltag blieben die Effekte aus – weder Medienkonsum noch KI-Nutzung sagten die Wahrnehmung oder das Generieren malevolenter Ideen vorher. Als mögliche Erklärung wurde die geringe Bereitschaft der Teilnehmenden diskutiert, entsprechende Gedanken überhaupt zu berichten. Das Fazit war dennoch beruhigend: Für eine direkte Verbindung zwischen True-Crime-Konsum und schädlichem Verhalten oder aggressiveren Affekten fanden sich bislang keine belastbaren Belege.
VORTRAG 3 | Kognitive Bausteine des Bösen – der Scrambled Sentences Task für antisoziale Kognitionen
Der dritte Vortrag stellte ein neu entwickeltes Messinstrument vor: den Scrambled Sentences Task (SST) für antisoziale Kognitionen. Das ursprünglich für depressionsbezogene Schemata entwickelte Verfahren wurde adaptiert, um zugrundeliegende antisoziale Denkweisen zu erfassen – und zwar nicht über Selbstauskunft, sondern über implizite Präferenzen.
Das Verfahren funktioniert so: Versuchspersonen erhalten sechs durcheinandergewürfelte Wörter und sollen daraus einen grammatikalisch korrekten Satz bilden. Dabei sind stets zwei semantisch korrekte Sätze möglich, die sich nur im letzten Wort unterscheiden – eines repräsentiert ein prosoziales, das andere ein antisoziales Schema. Die Entscheidung, welches Zielwort gewählt wird, gilt als Indikator für die zugrundeliegende kognitive Präferenz. Bildgebungsstudien belegen, dass diese Wahl weniger von exekutiven Funktionen als von Motivations- und Präferenzfaktoren gesteuert wird – was das Verfahren relativ robust gegenüber sozialer Erwünschtheit macht.
In drei Studien an unterschiedlichen Stichproben konnte gezeigt werden, dass dunkelheitere Persönlichkeitsmerkmale (gemessen über den D-Faktor sowie Antagonismus) – auch bekannt als Dunkle Triade – signifikant die Wahl des antisozialen Schemas vorhersagten. Besonders Sadismus zeigte in allen drei Studien einen signifikanten Interaktionseffekt mit der sogenannten Harm-Subskala – also dem Nutzen auf Kosten anderer. Ein unerwarteter Befund war ein zusätzlicher Effekt von Introversion, der unabhängig von der dunklen Persönlichkeit Varianz erklärte: Möglicherweise hängt sozialer Rückzug bei manchen Personen mit einer Wahrnehmung der Welt als gefährlichem Ort zusammen – ein Aspekt, der der weiteren Untersuchung bedarf. Insgesamt stellt der antisoziale SST ein valides und reliables Instrument dar, das antisoziale Kognitionen als eigenständige Kategorie – distinkt von depressionsbezogenen Schemata – abzubilden vermag.
VORTRAG 4 | Morbide Neugier – Pathologie oder adaptiver Mechanismus?
Den Abschluss bildete ein Vortrag über morbide Neugier: das menschliche Interesse an beängstigenden, verstörenden oder unheimlichen Dingen – von Unfallvideos im Internet über True Crime bis hin zu Geisterbahnen und Dunkeltourismus. Das Konzept, das bereits seit den 1980er Jahren bekannt ist, wurde kürzlich durch den amerikanischen Forscher Coltan Scrivner neu belebt, der vier Subtypen unterscheidet: Interesse an Körperverletzung, an zwischenmenschlicher Gewalt, an gefährlichen Personen sowie an paranormalen Gefahren.
Selbstberichtsdaten zeigen Zusammenhänge mit Furchtlosigkeit, Sensation Seeking und Gewaltmedienkonsum sowie negative Korrelationen mit Gewissenhaftigkeit und Ekelsensitivität – ein auf den ersten Blick eher düsteres Profil. Eine Ruhezustand-fMRT-Studie an 131 Personen zeichnete jedoch ein differenzierteres Bild: Morbide Neugier hängt mit Hirnregionen zusammen, die mit Informationssuche, kognitiver Flexibilität, Neubewertung, Vorstellungsvermögen und Theory of Mind assoziiert sind – also Fähigkeiten, die eher adaptiv als pathologisch anmuten.
Besonders aufschlussreich war ein Befund im Zusammenhang mit der COVID-19-Pandemie: Horror- und Apokalypsenfilm-Fans sowie generell morbid neugierige Personen reagierten deutlich weniger gestresst auf den Pandemiebeginn und fühlten sich besser vorbereitet. Die Hypothese: Wer sich kontrolliert und in sicherem Rahmen mit beängstigenden Szenarien auseinandersetzt, trainiert gleichsam seine mentale Resilienz – eine Art „mentales Fitnessstudio“. Studien zeigten zudem, dass Menschen mit mehr traumatischen Erfahrungen morbid neugieriger sind – was auf einen möglichen Bewältigungsmechanismus hindeutet. In Verhaltenstests generierten True-Crime-Konsumenten mehr Bewältigungsideen für angstauslösende Situationen und zeigten eine höhere Herzratenvariabilität in Emotionsregulationsphasen.
Das Fazit war bewusst nuanciert: Aus den Erkenntnissen ergibt sich keine pauschale Empfehlung für alle, mehr Morbides zu konsumieren – wohl aber steckt in morbider Neugier deutlich weniger Pathologie als zunächst vermutet. Ob sie adaptiv wirkt, hängt wesentlich von den individuellen Emotionsregulationsstrategien ab: Personen, die zur kognitiven Neubewertung fähig sind, profitieren offenbar eher, während maladaptive Strategien wie Katastrophisieren den gegenteiligen Effekt verstärken können.
Header © Freepik